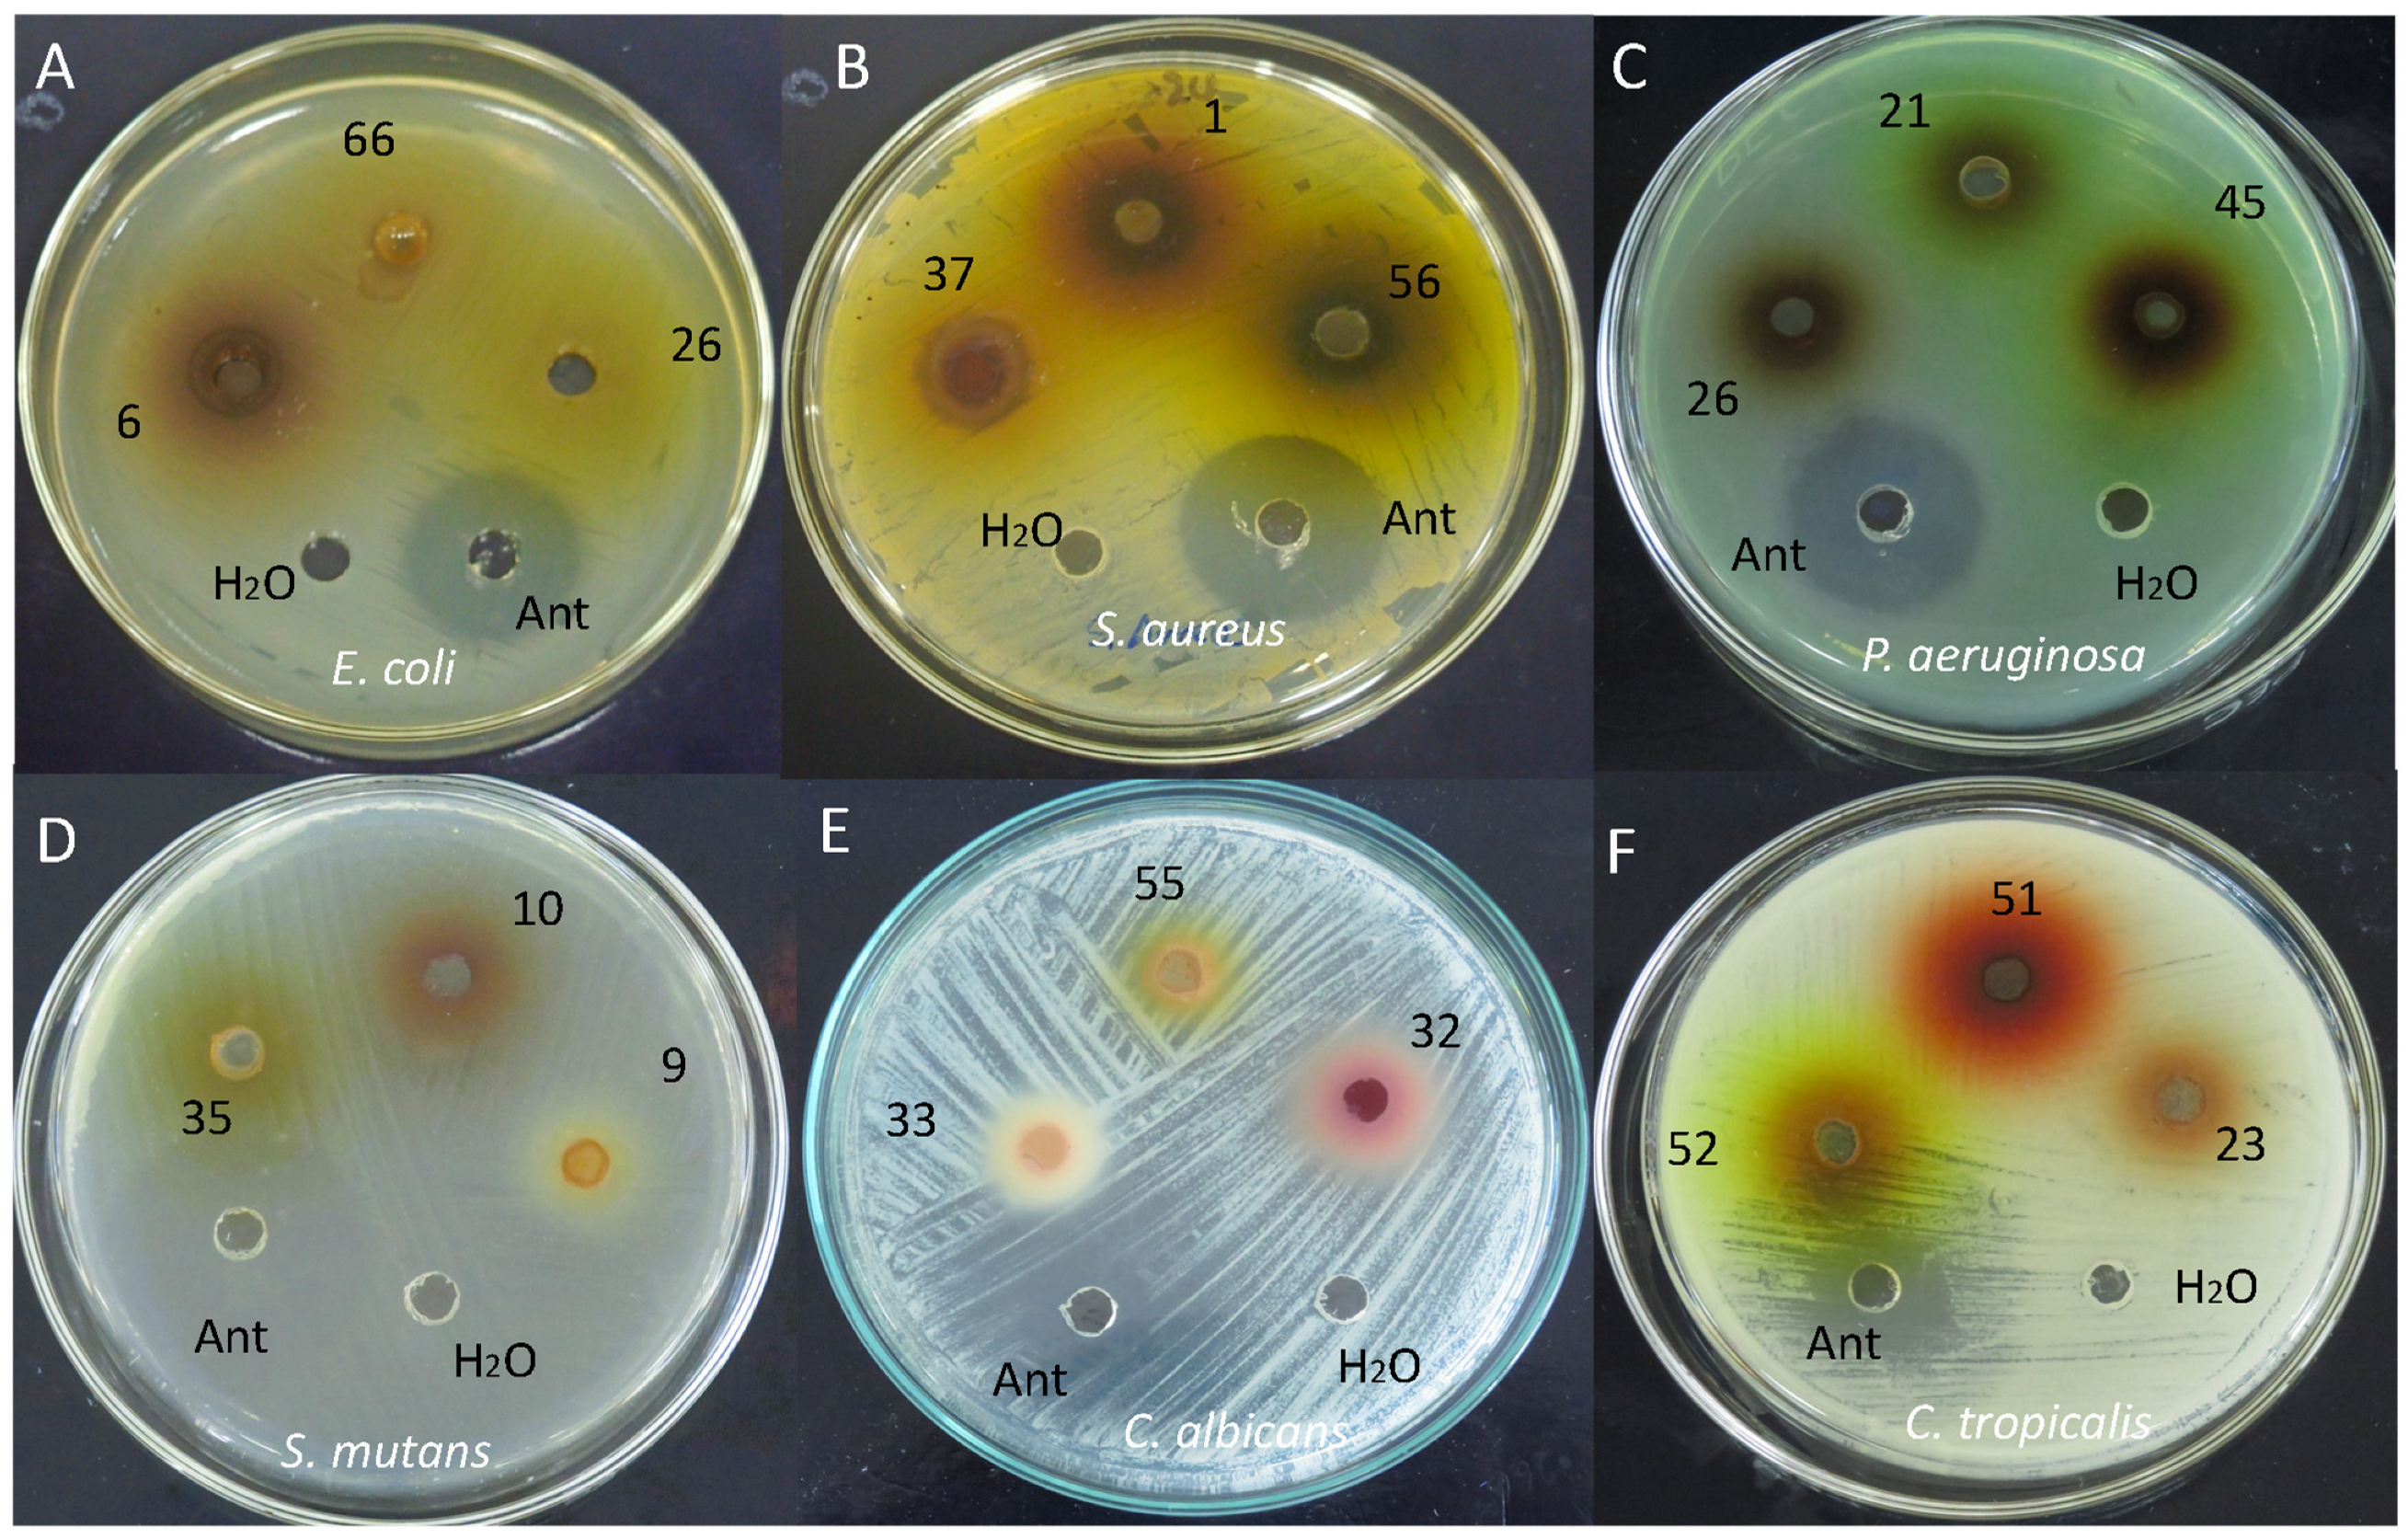
Foods 13 03766 g004

Bioactive Composition of Tropical Flowers and Their Antioxidant and Antimicrobial Properties
Abstract
1. Introduction
2. Materials and Methods
2.1. Reagents and Standards
2.2. Physicochemical Quantification
2.3. Optimization of Extraction Parameters and Quantification of Carotenoids
2.4. Optimization of Extraction Parameters Andquantification of Phenolic Compounds
2.5. Quantification of Total Anthocyanins
2.6. Quantification of Organic Acids
2.7. Antioxidant Activity (ABTS and DPPH)
2.8. Antimicrobial Activity
2.9. Statistical Analysis
3. Results
3.1. Physicochemical Quantification
3.2. Optimization of Extraction Parameters and Quantification of Carotenoids
3.3. Optimization of Extraction Parameters and Quantification of Phenolic Compounds
3.4. Quantification of Total Anthocyanins
3.5. Quantification of Organic Acids
3.6. Antioxidant Activity (ABTS and DPPH)
3.7. Antimicrobial Activity
3.8. Statistical Analysis
4. Discussion
4.1. Physicochemical Quantification
4.2. Optimization of Extraction Parameters and Quantification of Carotenoids
4.3. Optimization of Extraction Parameters and Quantification of Total Phenolic Compounds
4.4. Quantification of Total Anthocyanins
4.5. Quantification of Organic Acids
4.6. Antioxidant Activity (ABTS and DPPH)
4.7. Antimicrobial Activity
4.8. Statistical Analysis
5. Conclusions
Author Contributions
Funding
Institutional Review Board Statement
Informed Consent Statement
Data Availability Statement
Conflicts of Interest
References
- WWF. ¿Qué Son los Bosques Tropicales? Available online: https://www.wwf.org.co/en/?329990/Glosario-ambiental-Que-son-los-bosques-tropicales (accessed on 16 May 2023).
- Paz, A. Bosques Tropicales: Cada Día Es Más Urgente Su Conservación. Available online: https://es.mongabay.com/2021/06/bosques-tropicales-urgente-su-conservacion/ (accessed on 16 May 2023).
- Yusupova, Z.; Baratjon, S.; Rahimjon, Y. Chemical Composition of Medicinal Plants and Use in Medicine. Pedago. Resp. Ilmiy Jurnali 2023, 5, 30–36. [Google Scholar]
- Nwozo, O.S.; Effiong, E.M.; Aja, P.M.; Awuchi, C.G. Antioxidant, Phytochemical, and Therapeutic Properties of Medicinal Plants: A Review. Int. J. Food Prop. 2023, 26, 359–388. [Google Scholar] [CrossRef]
- Meléndez-Martínez, A.; Benítez, A.; Corell, M.; Hernanz, D.; Mapelli-Brahm, P.; Stinco, C.; Coyago-Cruz, E. Screening for Innovative Sources of Carotenoids and Phenolic Antioxidants among Flowers. Foods 2021, 10, 2625. [Google Scholar] [CrossRef] [PubMed]
- Horackova, J.; Elena, M.; Zans, C.; Kokoska, L.; Sulaiman, N.; Mirella, Z.; Peralta, C. Ethnobotanical Inventory of Medicinal Plants Used by Cashinahua (Huni Kuin) Herbalists in Purus Province, Peruvian Amazon. J. Ethnobiol. Ethnomed. 2023, 19, 16. [Google Scholar] [CrossRef] [PubMed]
- Foghis, M.; Bungau, S.G.; Bungau, A.F.; Vesa, C.M.; Purza, A.L.; Tarce, A.G.; Tit, D.M.; Pallag, A.; Behl, T.; ul Hassan, S.S.; et al. Plants-Based Medicine Implication in the Evolution of Chronic Liver Diseases. Biomed. Pharmacother. 2023, 158, 114207. [Google Scholar] [CrossRef]
- Dincheva, I.; Badjakov, I.; Galunska, B. New Insights into the Research of Bioactive Compounds from Plant Origins with Nutraceutical and Pharmaceutical Potential. Plants 2023, 12, 258. [Google Scholar] [CrossRef]
- Coyago-Cruz, E. Estudio Sobre el Contenido en Carotenoides y Compuestos Fenólicos de Tomates y Flores en el Contexto de la Alimentación Funcional. Doctoral Thesis, Departamento de Ciencias Agroforestales, Universidad de Sevilla, Seville, Spain, 2017. [Google Scholar]
- Williamson, G. The Role of Polyphenols in Modern Nutrition. Nutr. Bull. 2017, 42, 226–235. [Google Scholar] [CrossRef]
- Xu, D.P.; Li, Y.; Meng, X.; Zhou, T.; Zhou, Y.; Zheng, J.; Zhang, J.J.; Li, H. Bin Natural Antioxidants in Foods and Medicinal Plants: Extraction, Assessment and Resources. Int. J. Mol. Sci. 2017, 18, 96. [Google Scholar] [CrossRef]
- Coyago-Cruz, E.; Baldeón, M. Novel List of Ecuadorian Flowers with Antimicrobial Activity. In Medicinal Plants of Ecuador; CRC Press: Boca Raton, FL, USA; Taylor Francis Group: Boca Raton, FL, USA, 2022; p. 229. ISBN 9780367775865. [Google Scholar]
- Sierra-Vargas, M.P.; Montero-Vargas, J.M.; Debray-García, Y.; Vizuet-de-Rueda, J.C.; Loaeza-Román, A.; Terán, L.M. Oxidative Stress and Air Pollution: Its Impact on Chronic Respiratory Diseases. Int. J. Mol. Sci. 2023, 24, 853. [Google Scholar] [CrossRef]
- Liu, X.; Wang, S.; Cui, L.; Zhou, H.; Liu, Y.; Meng, L.; Chen, S.; Xi, X.; Zhang, Y.; Kang, W. Flowers: Precious Food and Medicine Resources. Food Sci. Hum. Wellness 2023, 12, 1020–1052. [Google Scholar] [CrossRef]
- Al-Hazmi, M.; Noorwali, E. Morning Individuals in Saudi Arabia Have Higher Self-Regulation of Eating Behavior Compared to Evening Types. Chronobiol. Int. 2023, 40, 223–233. [Google Scholar] [CrossRef] [PubMed]
- Azevedo-Meleiro, C.H.; Rodriguez-Amaya, D.B. Qualitative and Quantitative Differences in Carotenoid Composition among Cucurbita moschata, Cucurbita maxima, and Cucurbita pepo. J. Agric. Food Chem. 2007, 55, 4027–4033. [Google Scholar] [CrossRef] [PubMed]
- Jara-Palacios, M.J.; Hernanz, D.; González-Manzano, S.; Santos-Buelga, C.; Escudero-Gilete, M.L.; Heredia, F.J. Detailed Phenolic Composition of White Grape By-Products by RRLC/MS and Measurement of the Antioxidant Activity. Talanta 2014, 125, 51–57. [Google Scholar] [CrossRef] [PubMed]
- Coyago-Cruz, E.; Coronel, M.; Baldeón, M.; Vera, E. Physicochemical Characteristics and Antioxidant Capacity of Yellow and Orange Andean Floral Species. Commun. Smart Technol. Innov. Soc. 2022, 252, 1–175. [Google Scholar]
- Coyago-Cruz, E.; Guachamin, A.; Vera, E.; Moya, M.; Heredia-Moya, J.; Beltrán, E. Physicochemical Characteristics and Antioxidant Capacity of Ecuadorian Paramo Flowers. Rev. Bionatura 2023, 8, 21. [Google Scholar] [CrossRef]
- Coyago-Cruz, E.; Alarcón, A.; Guachamin, A.; Méndez, G.; Osorio, E.; Heredia-Moya, J.; Zuñiga-Miranda, J.; Beltrán-Sinchiguano, E.; Vera, E. Functional, Antioxidant, Antibacterial, and Antifungal Activity of Edible Flowers. Antioxidants 2024, 13, 1297. [Google Scholar] [CrossRef]
- Periago, M.J.; Martínez-Valverde, I.; Chesson, A.; Provan, G. Phenolic Compounds, Lycopene and Antioxidant Activity in Commercial Varieties of Tomato (Lycopersicum esculentum). J. Sci. Food Agric. 2002, 82, 323–330. [Google Scholar] [CrossRef]
- Bobo-García, G.; Davidov-Pardo, G.; Arroqui, C.; Vírseda, P.; Marín-Arroyo, M.R.; Navarro, M. Intra-Laboratory Validation of Microplate Methods for Total Phenolic Content and Antioxidant Activity on Polyphenolic Extracts, and Comparison with Conventional Spectrophotometric Methods. J. Sci. Food Agric. 2015, 95, 204–209. [Google Scholar] [CrossRef]
- Tan, J.; Han, Y.; Han, B.; Qi, X.; Cai, X.; Ge, S.; Xue, H. Extraction and Purification of Anthocyanins: A Review. J. Agric. Food Res. 2022, 8, 100306. [Google Scholar] [CrossRef]
- Tian, Y.; Yang, Y.; Gao, P.; Hong, J.; Qin, Y.; Yuan, Z. Optimization of Ultrasonic-Assisted Extraction of Flavonols and Anthocyanins from Blueberry Using RSM. Adv. Mater. Res. 2012, 4, 2423–2430. [Google Scholar] [CrossRef]
- Yuniati, Y.; Elim, P.; Alfanaar, R.; Kusuma, H.; Mahfud. Extraction of Anthocyanin Pigment from Hibiscus sabdariffa L. by Ultrasonic-Assisted Extraction. IOP Conf. Ser. Mater. Sci. Eng. 2021, 1010, 012032. [Google Scholar] [CrossRef]
- Lee, J.; Rennaker, C.; Wrolstad, R. Correlation of Two Anthocyanin Quantification Methods: HPLC and Spectrophotometric Methods. Food Chem. 2008, 110, 782–786. [Google Scholar] [CrossRef]
- Lee, J.; Durst, R.; Wrolstad, R. Determination of Total Monomeric Anthocyanin Pigment Content of Fruit Juices, Beverages, Natural Colorants, and Wines by the PH Differential Method: Collaborative Study. J. AOAC Int. 2005, 88, 1269–1278. [Google Scholar] [CrossRef] [PubMed]
- Chan, Y.; Cheng, N.; Nigam, P.; Owusu-Apenten, R. Effect of PH on the Radical Quenching Capacity of Tea Infusions Using the ABTS•+ Assay. J. Appl. Life Sci. Int. 2016, 6, 1–8. [Google Scholar] [CrossRef] [PubMed]
- Coyago-Cruz, E.; Guachamin, A.; Villacís, M.; Rivera, J.; Neto, M.; Méndez, G.; Heredia-Moya, J.; Vera, E. Evaluation of Bioactive Compounds and Antioxidant Activity in 51 Minor Tropical Fruits of Ecuador. Foods 2023, 12, 4439. [Google Scholar] [CrossRef]
- CLSI M02; Performance Standards for Antimicrobial Disk Suspectibility Tests, Approved Standard-Eleventh Edition. Clinical and Laboratory Standards Institue: Malvern, PA, USA, 2018; Volume 38, pp. 2162–2914.
- CLSI M44-A2; Method for Antifungal Disk Diffusion Susceptibility Testing of Yeasts. Approved Guideline—Second Edition. Clinical and Laboratory Standards Institue: Malvern, PA, USA, 2009; Volume 29, p. 29.
- Balouiri, M.; Sadiki, M.; Ibnsouda, S. Methods for in Vitro Evaluating Antimicrobial Activity: A Review. J. Pharm. Anal. 2016, 6, 71–79. [Google Scholar] [CrossRef]
- Coyago-Cruz, E.; Moya, M.; Méndez, G.; Villacís, M.; Rojas-Silva, P.; Corell, M.; Mapelli-Brahm, P.; Vicario, I.; Meléndez-Martínez, A. Exploring Plants with Flowers: From Therapeutic Nutritional Benefits to Innovative Sustainable Uses. Foods 2023, 12, 4066. [Google Scholar] [CrossRef]
- WFO. The World Flora Online. Available online: https://wfoplantlist.org/plant-list (accessed on 14 June 2024).
- Ramírez-Cortés, B.; Caro-Velarde, F.; Valdivia-Reynoso, M.; Ramírez-Lozano, M.; Machuca-Sánchez, L. Cambios En Tamaño y Características Químicas de Cálices de Jamaica (Hibiscus sabdariffa L.) Durante Su Maduración. Rev. Chapingo Ser. Hortic. 2011, XVII, 19–31. [Google Scholar] [CrossRef]
- Cho, L.; Yoon, J.; An, G. The Control of Flowering Time by Environmental Factors. Plant J. 2017, 90, 708–719. [Google Scholar] [CrossRef]
- Bhatla, S.; Lal, M. Plant Physiology. Development and Metabolism; Springer: Berlin/Heidelberg, Germany, 2023; ISBN 9789811320231. [Google Scholar]
- Khristi, V.; Patel, V.H. Therapeutic Potential of Hibiscus Rosa Sinensis: A Review. Int. J. Nutr. Diet. 2017, 4, 105–123. [Google Scholar] [CrossRef]
- Abdullah; Mehmood, F.; Shahzadi, I.; Waseem, S.; Mirza, B.; Ahmed, I.; Waheed, M.T. Chloroplast Genome of Hibiscus rosa-sinensis (Malvaceae): Comparative Analyses and Identification of Mutational Hotspots. Genomics 2020, 112, 581–591. [Google Scholar] [CrossRef] [PubMed]
- Slamet, A. The Diversity of Hibiscus rosa-sinensis Based on Morphological Approach. Sci. Educ. 2018, 7, 32. [Google Scholar] [CrossRef]
- Hapsari, L.; Trimanto; Wahyudi, D. Species Diversity and Phylogenetic Analysis of Heliconia spp. Collections of Purwodadi Botanic Garden (East Java, Indonesia) Inferred by RbcL Gene Sequences. Biodiversitas 2019, 20, 1266–1283. [Google Scholar] [CrossRef]
- Daniel, T.; Acosta, S. Flora del Bajío y de Regiones Adyacentes; INECOL Instituto de Ecología, A.C.: Pátzcuaro, Mexico, 2003; pp. 1–158. [Google Scholar] [CrossRef]
- Acurio, C. Análisis de la Influencia del Estado de Conservación de los Humedales Altoandinos del Parque Nacional Cajas y la Reserva Ecológica Antisana en el Secuestro de Carbono. Master’s Thesis, Universidad UTE, Maestría en Ecoturismo y Manejo de Áreas Naturales Quito, Quito, Ecuador, 2015. [Google Scholar]
- Rodríguez, F. Identificación de Procesos de Erosión por Monocultivo en la Parroqui de Pacto y Propuestas de Lineas de Acción. Universidad UTE, Facultad de Ciencias de la Ingeniería e Industrias: Quito, Ecuador, 2019. [Google Scholar]
- Domene, M.; Segura, M. Parámetros de Calidad Interna de Hortalizas y Frutas en la Industria Agroalimentaria; Cajamar Caja Rural: Almería, Spain, 2014. [Google Scholar]
- Li, C.; He, M.; Cai, Z.; Qi, H.; Zhang, J.; Zhang, C. Hyperspectral Imaging with Machine Learning Approaches for Assessing Soluble Solids Content of Tribute Citru. Foods 2023, 12, 247. [Google Scholar] [CrossRef] [PubMed]
- Magri, A.; Adiletta, G.; Petriccione, M. Evaluation of Antioxidant Systems and Ascorbate-Glutathione Cycle in Feijoa Edible Flowers at Different Flowering Stages. Foods 2020, 9, 95. [Google Scholar] [CrossRef]
- De-Lima, F.; Rodrigues, M.; Lidório, H.; Menegaes, J.; Martins, L. Chemical Composition of Rose, Sunflower and Calendula Flower Petals for Human Food Use. Cienc. Tecnol. Agropecu. 2019, 20, 159–168. [Google Scholar] [CrossRef]
- Afify, A.; Hassan, H. Free Radical Scavenging Activity of Three Different Flowers—Hibiscus rosa-sinensis, Quisqualis indica and Senna surattensis. Asian Pac. J. Trop. Biomed. 2016, 6, 771–777. [Google Scholar] [CrossRef]
- Hameed, A.; Nawaz, G.; Gulzar, T. Chemical Composition, Antioxidant Activities and Protein Profiling of Different Parts of Allamanda Cathartica. Nat. Prod. Res. 2014, 28, 2066–2071. [Google Scholar] [CrossRef]
- Gómez-Betancur, I.; Benjumea, D. Traditional Use of the Genus Renealmia and Renealmia alpinia (Rottb.) Maas (Zingiberaceae)—A Review in the Treatment of Snakebites. Asian Pac. J. Trop. Med. 2014, 7, S574–S582. [Google Scholar] [CrossRef]
- Kumar, N.; Khan, N. Phytochemical Investigation and Antidepressant Activity of Celosia cristata Leaves and Flowers in Experimental Animals. Phytochem. Investig. Antidepressant Act. Celosia Cris. 2023, 12, 298–305. [Google Scholar]
- Torres-Guevara, F.; Ganoza-Yupanqui, M.; Mantilla-Rodriguez, E.; Suárez-Rebaza, L.; Bussmann, R. Ethnobotany of Fruit Species Native to Paramos and Cloud Forests of Northern Peru. Ethnobot. Res. Appl. 2023, 25, 10. [Google Scholar] [CrossRef]
- Mu, K.; Liu, Y.; Liu, G.; Ran, F.; Zhou, L.; Wu, Y.; Peng, L.; Shao, M.; Li, C.; Zhang, Y. A Review of Hemostatic Chemical Components and Their Mechanisms in Traditional Chinese Medicine and Ethnic Medicine. J. Ethnopharmacol. 2023, 307, 116200. [Google Scholar] [CrossRef] [PubMed]
- Kaczmarek-Szczepańska, B.; Grabska-Zielińska, S.; Michalska-Sionkowska, M. The Application of Phenolic Acids in the Obtainment of Packaging Materials Based on Polymers—A Review. Foods 2023, 12, 1343. [Google Scholar] [CrossRef] [PubMed]
- Gontova, T.; Mashtaler, V.; Romanova, S.; Maloshtan, L.; Shanaida, M. Phytochemical Analysis of Anthocyanins Extracted from the Flowers of Two Dahlia Cultivars and Their Cytotoxic Properties. Biomed. Pharmacol. J. 2024, 17, 735–749. [Google Scholar] [CrossRef]
- Bal, A.; Shilpa, H.; Debnath, S.; Rastogi, N. Extraction of Anthocyanin from Hibiscus rosa-sinensis and Concentration by Forward Osmosis Membrane Process. Innov. Food Sci. Emerg. Technol. 2024, 96, 103782. [Google Scholar] [CrossRef]
- Izquierdo-Vega, J.; Arteaga-Badillo, D.; Sánchez-Gutiérrez, M.; Morales-González, J.; Vargas-Mendoza, N.; Gómez-Aldapa, C.; Castro-Rosas, J.; Delgado-Olivares, L.; Madrigal-Bujaidar, E.; Madrigal-Santillán, E. Organic Acids from Roselle (Hibiscus sabdariffa L.)—A Brief Review of Its Pharmacological Effects. Biomedicines 2020, 8, 100. [Google Scholar] [CrossRef]
- Ma, W.-F.; Li, Y.-B.; Nai, G.-J.; Liang, G.-P.; Ma, Z.-H.; Chen, B.-H.; Mao, J. Changes and Response Mechanism of Sugar and Organic Acids in Fruits under Water Deficit Stress. PeerJ 2022, 10, e13691. [Google Scholar] [CrossRef]
- Mignard, P.; Beguería, S.; Giménez, R.; Forcada, C.; Reig, G.; Moreno, M. Effect of Genetics and Climate on Apple Sugars and Organic Acids Profiles. Agronomy 2022, 12, 827. [Google Scholar] [CrossRef]
- Walker, R.P.; Famiani, F. Organic Acids in Fruits: Metabolism, Functions and Contents. In Horticultural Reviews; Wiley: Hoboken, NJ, USA, 2018; Volume 45, pp. 371–430. ISBN 9781119431077. [Google Scholar]
- Shi, Y.; Pu, D.; Zhou, X.; Zhang, Y. Recent Progress in the Study of Taste Characteristics and the Nutrition and Health Properties of Organic Acids in Foods. Foods 2022, 11, 3408. [Google Scholar] [CrossRef]
- Cano, A.; Maestre, A.; Hernández-Ruiz, J.; Arnao, M. ABTS/TAC Methodology: Main Milestones and Recent Applications. Processes 2023, 11, 185. [Google Scholar] [CrossRef]
- Cano, A.; Arnao, M. ABTS/TEAC (2,2′-Azino-Bis(3-Ethylbenzothiazoline-6-Sulfonic Acid)/Trolox®—Equivalent Antioxidant Capacity) Radical Scavenging Mixed—Mode Assay. In Measurement of Antioxidant Activity Capacity: Recent Trends and Applications; Apak, R., Capanuglu, E., Shahidi, F., Eds.; Wiley Online Library: Hoboken, NJ, USA, 2018; pp. 117–139. ISBN 9781119135357. [Google Scholar]
- Platzer, M.; Kiese, S.; Herfellner, T.; Schweiggert-Weisz, U.; Miesbauer, O.; Eisner, P. Common Trends and Differences in Antioxidant Activity Analysis of Phenolic Substances Using Single Electron Transfer Based Assays. Molecules 2021, 26, 1244. [Google Scholar] [CrossRef] [PubMed]
- Müller, L.; Fröhlich, K.; Böhm, V. Comparative Antioxidant Activities of Carotenoids Measured by Ferric Reducing Antioxidant Power (FRAP), ABTS Bleaching Assay (ATEAC), DPPH Assay and Peroxyl Radical Scavenging Assay. Food Chem. 2011, 129, 139–148. [Google Scholar] [CrossRef]
- Van-Den-Berg, R.; Haenen, G.; Van-Den-Berg, H.; Bast, A. Applicability of an Improved Trolox Equivalent Antioxidant Capacity (TEAC) Assay for Evaluation of Antioxidant Capacity Measurements of Mixtures. Food Chem. 1999, 66, 511–517. [Google Scholar] [CrossRef]
- Kuskoski, E.; Asuero, A.; Troncoso, A.; Mancini-Filho, J.; Fett, R. Aplicación de Diversos Métodos Químicos Para Determinar Actividad Antioxidante En Pulpa de Frutos. Ciênc. Tecnol. Aliment. 2005, 25, 726–732. [Google Scholar] [CrossRef]
- Arias, A.; Feijoo, G.; Moreira, M. Exploring the Potential of Antioxidants from Fruits and Vegetables and Strategies for Their Recovery. Innov. Food Sci. Emerg. Technol. 2022, 77, 102974. [Google Scholar] [CrossRef]
- Da-Silva, E.; Queiroz, V.; Nascimento, D.; Pereira, M.; Pereira, L.; Dantas, J.; De-Freitas, F.; Gomez, A.; Do-Amaral, F.; De-Barros, E. The Role of Phenolic Compounds in Metabolism and Their Antioxidant. Res. Soc. Dev. 2022, 11, 1–12. [Google Scholar] [CrossRef]
- Luo, Y.; Xu, Y.; Zhang, H.; Zhang, J.; Qin, X.; Jin, S. Celosia cristata L.: A Review of Its Traditional Uses, Phytochemistry, Pharmacology, Toxicology, and Quality Control, along with Network Pharmacological Analysis of Its Components and Targets. J. Ethnopharmacol. 2024, 332, 118325. [Google Scholar] [CrossRef]
- Khare, T.; Anand, U.; Dey, A.; Assaraf, Y.; Chen, Z.; Liu, Z.; Kumar, V. Exploring Phytochemicals for Combating Antibiotic Resistance in Microbial Pathogens. Front. Pharmacol. 2021, 12, 720726. [Google Scholar] [CrossRef]
- Dębczak, A.; Grzegorczyk, A.; Świątek, Ł.; Sandomierski, M.; Fekner, Z.; Tyśkiewicz, K.; Milovanovic, S. Green and Sustainable Recovery of Polyphenols, Flavonoids, Alkaloids, and Pigments from Green Tea Leaves: Comparative Analysis of Soxhlet, Accelerated Solvent, and Supercritical Fluid Extraction Techniques. Sustain. Chem. Pharm. 2024, 42, 101810. [Google Scholar] [CrossRef]
- Ondusko, D.; Nolt, D. Staphylococcus aureus. Pediatr. Rev. 2018, 39, 287–298. [Google Scholar] [CrossRef]
- Khameneh, B.; Eskin, N.; Iranshahy, M.; Fazly, B. Phytochemicals: A Promising Weapon in the Arsenal against Antibiotic-resistant Bacteria. Antibiotics 2021, 10, 1044. [Google Scholar] [CrossRef] [PubMed]
- Wardoyo, E.; Hildayati, U.; Rachmawati; Kurniatuhadi, R. Phytochemical Analysis and Antifungi Activity of Methanol Extract of Acalypha hispida Burm. F. Flower against to Candida albicans (Y116). J. Phys. Conf. Ser. 2021, 1940, 012056. [Google Scholar] [CrossRef]
- Narayanan, A.; Palaniappan, S. Evaluation of Mussaenda erythrophylla Schumach. & Thonn. for Anthelmintic Activity. Int. J. Res. Pharm. Sci. 2021, 12, 77–80. [Google Scholar] [CrossRef]
- Hajare, C.; Inamdar, F.; Patil, R.; Shete, C.; Wadkar, S.; Patil, K.; Ghosh, J. Antibacterial Activity of the Leaves of Bougainvillea spectabilis against E. coli NCIM 2832 and M. aureus NCIM 5021. Int. J. Pharm. Sci. Rev. Res. 2015, 34, 194–196. [Google Scholar]
- Makerly, H.; Hashim, Z. Antibacterial Activity and Metabolite Content of Water and Methanolic Extracts of Purple and White Bougainvillea sp. J. Bioprocess. Biomass Technol. 2024, 3, 33–40. [Google Scholar] [CrossRef]
- Ravikumar, P.; Thangaraj, P. Anti-Bacterial Attributes of Phytochemicals from Bougainvillaea spectabilis: Computational Approach. Pharmacogn. Res. 2024, 16, 384–390. [Google Scholar] [CrossRef]
- Dame-Teixeira, N.; El-Gendy, R.; Monici, I.; Holanda, C.; De-Oliveira, A.; Romeiro, L.; Do, T. Sustainable Multifunctional Phenolic Lipids as Potential Therapeutics in Dentistry. Sci. Rep. 2022, 12, 9299. [Google Scholar] [CrossRef]
- Wang, X.; Li, J.; Zhang, S.; Zhou, W.; Zhang, L.; Huang, X. PH-Activated Antibiofilm Strategies for Controlling Dental Caries. Front. Cell. Infect. Microbiol. 2023, 13, 1130506. [Google Scholar] [CrossRef]
- Beladi, S.; Kiridena, S.D.; Wijayaratna, U.; Taylor, C.; Anker, J.; Tzeng, T.-R. PH Variation in Medical Implant Biofilms: Causes, Measurements, and Its Implications for Antibiotic Resistance. Front. Microbiol. 2022, 13, 1028560. [Google Scholar] [CrossRef]

| N° | Family | Species | Altitude (masl) |
|---|---|---|---|
| 1 | Acanthaceae | Megaskepasma erythrochlamys Lindau | 1020 |
| 2 | Acanthaceae | Odontonema cuspidatum (Nees) Kuntze | 562 |
| 3 | Acanthaceae | Pachystachys lutea Nees | 981 |
| 4 | Acanthaceae | Sanchezia oblonga Ruiz & Pav. | 1382 |
| 5 | Acanthaceae | Thunbergia grandiflora Roxb. | 1240 |
| 6 | Amaranthaceae | Celosia argentea L. | 136 |
| 7 | Apiaceae | Eryngium aquaticum L. | 1260 |
| 8 | Apocynaceae | Allamanda cathartica L. | 40 |
| 9 | Araceae | Philodendron fragrantissimum (Hook.) G.Don | 562 |
| 10 | Araceae | Philodendron strictum G.S. Bunting | 562 |
| 11 | Araceae | Xanthosoma robustum Schott | 620 |
| 12 | Asteraceae | Acmella papposa (Hemsl.) R.K. Jansen | 1486 |
| 13 | Asteraceae | Dahlia pinnata Cav. | 2222 |
| 14 | Asteraceae | Dendrophorbium balsapampae (Cuatrec.) B. Nord. | 2447 |
| 15 | Asteraceae | Pseudogynoxys chenopodioides (Kunth) Cabrera | 1360 |
| 16 | Balsaminaceae | Impatiens hancockii C.H.Wright. | 2593 |
| 17 | Balsaminaceae | Impatiens hawkeri W. Bull | 630 |
| 18 | Balsaminaceae | Impatiens sodenii Engl. & Warb. ex Engl. | 2814 |
| 19 | Balsaminaceae | Impatiens walleriana Hook.f. | 630 |
| 20 | Bromeliaceae | Aechmea corymbosa (Mart. Ex Schult. & Schult.f.) Mez | 1506 |
| 21 | Bromeliaceae | Guzmania nicaraguensis Mez & Baker | 1580 |
| 22 | Bromeliaceae | Ronnbergia veitchii (Baker) Aguirre-Santoro | 1337 |
| 23 | Campanulaceae | Centropogon cornutus (L.) Druce | 562 |
| 24 | Caricaceae | Carica papaya L. | 562 |
| 25 | Convolvulaceae | Ipomoea triloba L. | 16 |
| 26 | Costaceae | Costus spiralis (Jacq.) Roscoe | 1320 |
| 27 | Clusiaceae | Clusia nitida Bittrich & F.N. Cabral | 1477 |
| 28 | Ericaceae | Cavendishia bracteata (Ruiz & Pav. Ex J.St.-Hil.) Hoerold | 2100 |
| 29 | Ericaceae | Cavendishia cuatrecasasii A.C.Sm. | 1910 |
| 30 | Ericaceae | Cavendishia nobilis Lindl. | 2060 |
| 31 | Ericaceae | Thibaudia floribunda Kunth | 1641 |
| 32 | Euphorbiaceae | Acalypha poiretii Spreng. | 620 |
| 33 | Fabaceae | Brownea macrophylla Linden | 940 |
| 34 | Fabaceae | Calliandra angustifolia Spruce ex Benth. | 1598 |
| 35 | Fabaceae | Erythrina americana Mill. | 562 |
| 36 | Gentianaceae | Macrocarpaea sodiroana Gilg | 1490 |
| 37 | Gesneriacea | Glossoloma ichthyoderma (Hanst.) J.L. Clark | 1495 |
| 38 | Heliconiaceae | Heliconia episcopalis Vell. | 620 |
| 39 | Heliconiaceae | Heliconia collinsiana Griggs | 1641 |
| 40 | Heliconiaceae | Heliconia latispatha Benth. | 1494 |
| 41 | Heliconiaceae | Heliconia rostrata Ruiz & Pav. | 562 |
| 42 | Heliconiaceae | Heliconia wagneriana Petersen | 562 |
| 43 | Lamiaceae | Prunella vulgaris L. | 1850 |
| 44 | Malvaceae | Hibiscus rosa-sinensis L. | 500 |
| 45 | Marantaceae | Stromanthe stromanthoides (J.F. Macbr.) L.Andersson | 530 |
| 46 | Melastomataceae | Pleroma heteromallum (D.Don) D. Don | 1260 |
| 47 | Melastomataceae | Andesanthus lepidotus (Humb. & Bonpl.) P.J.F.Guim. & Michelang. | 1742 |
| 48 | Melastomataceae | Chaetogastra mollis (Bonpl.) DC. | 1850 |
| 49 | Melastomataceae | Plerona urvilleanum (DC.) PJ:F:Gui. & Michelang. | 1234 |
| 50 | Musaceae | Musa velutina H. Wendl. & Drude | 562 |
| 51 | Nyctaginaceae | Bougainvillea spectabilis Willd. | 14 |
| 52 | Orchidaceae | Elleanthus aurantiacus (Lindl.) Rchb.f. | 2530 |
| 53 | Orchidaceae | Oncidium sp. | 306 |
| 54 | Orchidaceae | Sobralia liliastrum Lindl. | 1260 |
| 55 | Rubiaceae | Mussaenda erythrophylla Schumach. & Thonn. | 510 |
| 56 | Rubiaceae | Mussaenda philippica A. Rich. | 940 |
| 57 | Rubiaceae | Palicourea angustifolia Kunth | 510 |
| 58 | Solanaceae | Brugmansia arborea (L.) Sweet | 1641 |
| 59 | Solanaceae | Iochroma gesnerioides (Kunth) Miers | 2054 |
| 60 | Solanaceae | Browallia americana L. | 1477 |
| 61 | Solanaceae | Brugmansia versicolor Lagerh. | 2833 |
| 62 | Solanaceae | Solanum dulcamara L. | 1910 |
| 63 | Verbenaceae | Lantana rugulosa Kunth | 2798 |
| 64 | Zingiberaceae | Alpinia purpurata (Vieill.) K. Schum. | 14 |
| 65 | Zingiberaceae | Hedychium coronarium J. Koening | 940 |
| 66 | Zingiberaceae | Hedychium coccineum Buch.-Ham.exSm. | 1240 |
| 67 | Zingiberaceae | Renealmia alpinia (Rottb.) Maas | 940 |
| N° | Scientific Name | Weight (g) | DL (cm) | DE (cm) | pH | SS (°Brix) | TA (%) | Humidity (%) | Ash (%) |
|---|---|---|---|---|---|---|---|---|---|
| 1 | Megaskepasma erythrochlamys | 0.17 ± 0.03 | 4.21 ± 0.80 | 1.36 ± 0.36 | 9.15 ± 0.24 | 1.74 ± 0.22 | 1.44 ± 0.08 | 85.06 ± 3.32 | 0.18 ± 0.00 |
| 2 | Odontonema cuspidatum | 0.03 ± 0.00 | 1.69 ± 0.23 | 0.36 ± 0.08 | 4.60 ± 0.46 | 5.04 ± 0.05 | 0.25 ± 0.00 | 85.59 ± 0.18 | 3.53 ± 0.20 |
| 3 | Pachystachys lutea | 0.05 ± 0.02 | 1.77 ± 0.58 | 1.54 ± 0.82 | 7.00 ± 0.00 | 15.80 ± 0.42 | 1.44 ± 0.19 | 77.72 ± 4.23 | 3.46 ± 0.00 |
| 4 | Sanchezia oblonga | 4.16 ± 0.37 | 4.23 ± 1.01 | 4.16 ± 0.37 | 7.00 ± 0.00 | 4.00 ± 0.00 | 0.48 ± 0.05 | 81.8 ± 1.22 | 8.02 ± 0.29 |
| 5 | Thunbergia grandiflora | 1.44 ± 0.15 | 3.99 ± 0.25 | 7.93 ± 0.74 | 8.50 ± 0.00 | 7.00 ± 0.00 | 0.28 ± 0.02 | 56.98 ± 4.08 | 1.85 ± 0.08 |
| 6 | Celosia argentea | 21.33 ± 0.92 | 7.68 ± 0.33 | 9.52 ± 0.90 | 6.50 ± 0.00 | 3.94 ± 0.10 | 0.12 ± 0.00 | 80.53 ± 0.25 | 1.44 ± 0.21 |
| 7 | Eryngium aquaticum | 0.10 ± 0.02 | 1.32 ± 0.22 | 3.75 ± 1.01 | 5.50 ± 0.00 | 10.60 ± 0.97 | 0.59 ± 0.11 | 73.77 ± 1.40 | 2.21 ± 0.13 |
| 8 | Allamanda cathartica | 2.29 ± 0.42 | 9.22 ± 0.24 | 11.30 ± 0.44 | 6.00 ± 0.00 | 3.00 ± 0.00 | 0.94 ± 0.05 | 89.55 ± 0.27 | 0.51 ± 0.04 |
| 9 | Philodendron fragrantissimum | 5.72 ± 1.33 | 8.82 ± 1.25 | 1.06 ± 0.17 | 6.00 ± 0.00 | 0.21 ± 0.07 | 0.11 ± 0.01 | 84.35 ± 0.97 | 3.54 ± 0.29 |
| 10 | Philodendron strictum | 6.42 ± 1.92 | 8.74 ± 2.47 | 2.54 ± 0.48 | 4.00 ± 0.00 | 2.71 ± 0.22 | 0.19 ± 0.05 | 91.52 ± 0.34 | 1.28 ± 0.04 |
| 11 | Xanthosoma robustum | 72.79 ± 15.16 | 23.68 ± 3.11 | 2.24 ± 0.22 | 4.30 ± 0.48 | 3.00 ± 0.00 | 0.05 ± 0.01 | 91.77 ± 0.11 | 1.32 ± 0.01 |
| 12 | Acmella papposa | 0.06 ± 0.02 | 1.28 ± 0.08 | 1.62 ± 0.24 | 6.00 ± 0.00 | 5.14 ± 0.10 | 1.01 ± 0.15 | 76.63 ± 0.23 | 2.39 ± 0.00 |
| 13 | Dahlia pinnata | 18.70 ± 3.95 | 9.96 ± 1.19 | 9.93 ± 0.93 | 4.40 ± 0.52 | 5.40 ± 0.52 | 0.17 ± 0.06 | 92.63 ± 0.09 | 0.67 ± 0.00 |
| 14 | Dendrophorbium balsapampae | 0.32 ± 0.03 | 1.39 ± 0.11 | 0.89 ± 0.39 | 6.00 ± 0.00 | 3.85 ± 0.24 | 0.34 ± 0.04 | 76.71 ± 0.05 | 1.72 ± 0.08 |
| 15 | Pseudogynoxys chenopodioides | 0.46 ± 0.17 | 1.19 ± 0.24 | 1.48 ± 0.52 | 5.7 ± 0.48 | 2.40 ± 0.52 | 0.32 ± 0.08 | 73.16 ± 1.17 | 2.58 ± 0.22 |
| 16 | Impatiens hancockii | 1.02 ± 0.00 | 25.33 ± 3.02 | 25.33 ± 3.02 | 4.30 ± 0.48 | 3.92 ± 0.10 | 0.75 ± 0.02 | 93.85 ± 0.36 | 0.03 ± 0.00 |
| 17 | Impatiens hawkeri | 0.22 ± 0.03 | 5.7 ± 0.45 | 2.73 ± 0.58 | 2.40 ± 0.84 | 3.00 ± 0.00 | 0.83 ± 0.53 | 95.74 ± 0.32 | 0.53 ± 0.01 |
| 18 | Impatiens sodenii | 0.91 ± 0.21 | 3.51 ± 0.19 | 5.15 ± 0.33 | 4.00 ± 0.00 | 3.55 ± 0.44 | 0.58 ± 0.07 | 94.02 ± 1.33 | 0.34 ± 0.08 |
| 19 | Impatiens walleriana | 0.22 ± 0.07 | 1.51 ± 0.63 | 3.27 ± 1.07 | 2.00 ± 0.00 | 3.00 ± 0.00 | 0.29 ± 0.03 | 96.05 ± 0.19 | 0.60 ± 0.02 |
| 20 | Aechmea corymbosa | 0.27 ± 0.01 | 2.62 ± 0.26 | 0.65 ± 0.06 | 5.80 ± 0.42 | 2.00 ± 0.00 | 3.81 ± 0.45 | 90.10 ± 0.29 | 0.25 ± 0.02 |
| 21 | Guzmania nicaraguensis | 13.84 ± 2.41 | 10.30 ± 0.98 | 2.42 ± 0.26 | 7.00 ± 0.00 | 2.85 ± 0.24 | 0.27 ± 0.07 | 86.67 ± 0.08 | 0.98 ± 0.10 |
| 22 | Ronnbergia veitchii | 2.18 ± 0.63 | 5.31 ± 0.53 | 1.46 ± 0.17 | 6.60 ± 0.52 | 2.00 ± 0.00 | 0.62 ± 0.18 | 78.51 ± 2.15 | 0.81 ± 0.05 |
| 23 | Centropogon cornutus | 0.47 ± 0.08 | 4.80 ± 1.01 | 0.78 ± 0.12 | 5.00 ± 0.00 | 8.88 ± 0.27 | 0.29 ± 0.03 | 83.40 ± 0.14 | 0.15 ± 0.01 |
| 24 | Carica papaya | 0.33 ± 0.53 | 1.76 ± 0.81 | 0.38 ± 0.17 | 6.00 ± 0.00 | 1.00 ± 0.00 | 0.15 ± 0.01 | 87.73 ± 0.07 | 0.70 ± 0.37 |
| 25 | Ipomoea triloba | 0.17 ± 0.03 | 4.37 ± 0.48 | 1.83 ± 0.28 | 5.45 ± 0.44 | 10.06 ± 0.10 | 2.01 ± 0.31 | 90.12 ± 1.44 | 0.10 ± 0.01 |
| 26 | Costus spiralis | 13.37 ± 4.69 | 6.60 ± 1.30 | 2.45 ± 0.40 | 3.00 ± 0.00 | 3.70 ± 0.48 | 0.14 ± 0.01 | 66.10 ± 5.02 | 1.30 ± 0.09 |
| 27 | Clusia nitida | 7.23 ± 0.93 | 2.20 ± 0.34 | 3.45 ± 0.28 | 4.87 ± 0.02 | 4.08 ± 0.10 | 0.49 ± 0.02 | 90.52 ± 0.85 | 0.21 ± 0.00 |
| 28 | Cavendishia bracteata | 1.60 ± 0.15 | 4.46 ± 0.20 | 0.99 ± 0.11 | 2.73 ± 0.41 | 4.75 ± 0.18 | 0.27 ± 0.02 | 92.30 ± 0.31 | 0.83 ± 0.02 |
| 29 | Cavendishia cuatrecasasii | 0.61 ± 0.07 | 3.34 ± 0.16 | 0.52 ± 0.10 | 3.00 ± 0.00 | 4.56 ± 1.32 | 0.99 ± 0.09 | 92.28 ± 0.12 | 0.54 ± 0.01 |
| 30 | Cavendishia nobilis | 0.73 ± 0.14 | 3.27 ± 0.36 | 0.84 ± 0.12 | 4.00 ± 0.00 | 4.75 ± 0.41 | 0.20 ± 0.02 | 87.04 ± 0.06 | 0.81 ± 0.05 |
| 31 | Thibaudia floribunda | 0.16 ± 0.04 | 1.67 ± 0.19 | 0.47 ± 0.11 | 4.00 ± 0.00 | 2.53 ± 0.21 | 1.53 ± 0.18 | 91.10 ± 0.21 | 0.47 ± 0.00 |
| 32 | Acalypha poiretii | 2.08 ± 1.07 | 16.70 ± 7.39 | 0.70 ± 0.17 | 2.00 ± 0.00 | 6.10 ± 0.88 | 1.19 ± 0.09 | 75.26 ± 0.70 | 2.19 ± 0.14 |
| 33 | Brownea macrophylla | 2.38 ± 0.50 | 13.45 ± 2.88 | 32.48 ± 8.65 | 2.00 ± 0.94 | 12.00 ± 1.33 | 0.23 ± 0.04 | 84.17 ± 0.12 | 0.70 ± 0.07 |
| 34 | Calliandra angustifolia | 0.69 ± 0.12 | 3.32 ± 0.52 | 1.74 ± 0.33 | 3.45 ± 0.44 | 6.08 ± 0.29 | 1.15 ± 0.45 | 80.87 ± 1.64 | 0.75 ± 0.06 |
| 35 | Erythrina americana | 1.07 ± 0.17 | 8.10 ± 0.33 | 0.98 ± 0.16 | 6.00 ± 0.00 | 2.00 ± 0.00 | 0.36 ± 0.01 | 78.69 ± 0.89 | 0.87 ± 0.05 |
| 36 | Macrocarpaea sodiroana | 0.07 ± 0.02 | 4.00 ± 0.00 | 1.28 ± 0.55 | 2.18 ± 0.52 | 6.00 ± 0.00 | 2.00 ± 0.00 | 14.26 ± 1.48 | 0.46 ± 0.12 |
| 37 | Glossoloma ichthyoderma | 0.72 ± 0.28 | 3.38 ± 0.51 | 0.97 ± 0.19 | 5.00 ± 0.00 | 0.48 ± 0.23 | 0.25 ± 0.15 | 81.34 ± 0.54 | 1.81 ± 0.03 |
| 38 | Heliconia episcopalis | 2.18 ± 0.63 | 5.31 ± 0.53 | 1.46 ± 0.17 | 5.60 ± 0.39 | 3.68 ± 0.54 | 0.05 ± 0.01 | 84.74 ± 2.13 | 2.89 ± 0.15 |
| 39 | Heliconia collinsiana | 19.93 ± 2.42 | 13.43 ± 0.21 | 3.61 ± 0.30 | 4.45 ± 0.44 | 2.86 ± 0.05 | 0.53 ± 0.09 | 70.34 ± 0.74 | 0.66 ± 0.03 |
| 40 | Heliconia latispatha | 3.25 ± 0.62 | 11.20 ± 1.95 | 1.99 ± 0.12 | 8.00 ± 0.00 | 3.00 ± 0.00 | 0.37 ± 0.08 | 82.65 ± 0.99 | 3.11 ± 0.22 |
| 41 | Heliconia rostrata | 11.36 ± 2.46 | 8.51 ± 0.26 | 3.44 ± 0.18 | 6.00 ± 0.00 | 1.00 ± 0.00 | 0.21 ± 0.03 | 70.52 ± 0.56 | 3.98 ± 0.27 |
| 42 | Heliconia wagneriana | 29.04 ± 1.37 | 12.38 ± 0.69 | 7.78 ± 0.36 | 7.00 ± 0.00 | 1.04 ± 0.15 | 0.22 ± 0.04 | 85.64 ± 2.89 | 0.86 ± 0.03 |
| 43 | Prunella vulgaris | 0.01 ± 0.00 | 1.42 ± 0.11 | 0.36 ± 0.07 | 7.80 ± 0.26 | 6.70 ± 0.48 | 0.51 ± 0.01 | 84.43 ± 1.28 | 2.31 ± 0.01 |
| 44 | Hibiscus rosa-sinensis | 1.01 ± 0.00 | 24.43 ± 1.21 | 5.45 ± 0.91 | 5.00 ± 0.82 | 3.20 ± 0.26 | 0.28 ± 0.02 | 91.66 ± 0.52 | 0.35 ± 0.00 |
| 45 | Stromanthe stromanthoides | 0.19 ± 0.03 | 1.61 ± 0.21 | 0.45 ± 0.08 | 5.00 ± 0.00 | 4.60 ± 0.52 | 0.21 ± 0.01 | 76.92 ± 3.80 | 2.09 ± 0.06 |
| 46 | Pleroma heteromallum | 0.17 ± 0.23 | 1.65 ± 0.31 | 0.47 ± 0.06 | 6.00 ± 0.00 | 6.00 ± 0.00 | 2.73 ± 0.50 | 86.16 ± 0.50 | 1.02 ± 0.01 |
| 47 | Andesanthus lepidotus | 0.45 ± 0.09 | 5.12 ± 0.56 | 5.32 ± 0.69 | 2.45 ± 0.44 | 4.01 ± 0.09 | 1.10 ± 0.04 | 93.96 ± 0.00 | 0.33 ± 0.01 |
| 48 | Chaetogastra molis | 0.07 ± 0.01 | 2.08 ± 0.20 | 1.60 ± 0.41 | 3.00 ± 0.00 | 4.80 ± 0.42 | 2.8 ± 0.75 | 86.82 ± 0.05 | 2.53 ± 0.03 |
| 49 | Plerona urvilleanum | 0.46 ± 0.05 | 2.03 ± 0.32 | 5.18 ± 0.59 | 11.4 ± 0.52 | 9.20 ± 1.03 | 0.30 ± 0.08 | 88.21 ± 1.03 | 1.20 ± 0.04 |
| 50 | Musa velutina | 39.73 ± 6.53 | 9.89 ± 0.22 | 4.31 ± 0.41 | 4.30 ± 0.48 | 2.46 ± 0.05 | 1.03 ± 0.10 | 91.66 ± 0.52 | 1.13 ± 0.12 |
| 51 | Bougainvillea spectabilis | 0.36 ± 0.08 | 3.61 ± 0.44 | 3.06 ± 0.42 | 4.00 ± 0.00 | 3.00 ± 0.00 | 0.41 ± 0.02 | 83.57 ± 0.47 | 2.11 ± 0.24 |
| 52 | Elleanthus aurantiacus | 0.10 ± 0.03 | 1.37 ± 0.12 | 0.58 ± 0.10 | 5.50 ± 0.75 | 6.10 ± 0.32 | 0.43 ± 0.04 | 90.5 ± 1.69 | 1.60 ± 0.25 |
| 53 | Oncidium sp. | 1.29 ± 0.40 | 2.82 ± 0.53 | 5.65 ± 0.38 | 2.70 ± 0.48 | 11.20 ± 1.32 | 0.39 ± 0.02 | 89.80 ± 0.56 | 0.39 ± 0.07 |
| 54 | Sobralia liliastrum | 6.62 ± 2.23 | 12.09 ± 1.77 | 2.09 ± 0.34 | 5.50 ± 0.41 | 4.58 ± 1.46 | 0.14 ± 0.02 | 92.70 ± 0.14 | 0.56 ± 0.02 |
| 55 | Mussaenda erythrophylla | 0.61 ± 0.16 | 5.64 ± 0.43 | 7.89 ± 1.32 | 5.60 ± 0.52 | 5.00 ± 1.05 | 0.29 ± 0.02 | 77.96 ± 1.92 | 3.35 ± 0.19 |
| 56 | Mussaenda philippica | 0.39 ± 0.18 | 4.25 ± 1.21 | 2.93 ± 0.53 | 6.40 ± 0.52 | 11.00 ± 0.67 | 0.61 ± 0.06 | 78.56 ± 0.69 | 1.36 ± 0.09 |
| 57 | Palicourea angustifolia | 0.24 ± 0.04 | 2.52 ± 0.27 | 0.52 ± 0.05 | 5.60 ± 0.21 | 4.00 ± 0.27 | 0.24 ± 0.03 | 87.85 ± 0.35 | 1.20 ± 0.01 |
| 58 | Brugmansia arborea | 11.54 ± 2.67 | 22.93 ± 3.84 | 4.09 ± 0.36 | 5.23 ± 0.56 | 6.62 ± 1.27 | 0.60 ± 0.04 | 87.34 ± 5.40 | 0.49 ± 0.05 |
| 59 | Iochroma gesnerioides | 0.30 ± 0.05 | 3.14 ± 0.30 | 0.45 ± 0.04 | 5.00 ± 0.00 | 5.41 ± 0.41 | 2.68 ± 0.12 | 86.14 ± 0.15 | 0.30 ± 0.03 |
| 60 | Browallia americana | 0.02 ± 0.00 | 1.67 ± 0.07 | 1.35 ± 0.26 | 6.45 ± 0.44 | 4.00 ± 0.00 | 0.31 ± 0.01 | 87.39 ± 0.69 | 0.95 ± 0.06 |
| 61 | Brugmansia versicolor | 10.91 ± 2.52 | 17.66 ± 2.99 | 8.76 ± 0.96 | 6.40 ± 0.52 | 7.00 ± 0.00 | 0.60 ± 0.04 | 88.96 ± 0.45 | 0.85 ± 0.02 |
| 62 | Solanum dulcamara | 0.10 ± 0.02 | 2.20 ± 0.36 | 1.78 ± 0.51 | 10.10 ± 0.77 | 3.68 ± 0.99 | 1.24 ± 0.25 | 91.00 ± 0.32 | 0.98 ± 0.03 |
| 63 | Lantana rugulosa | 0.01 ± 0.00 | 1.07 ± 0.11 | 1.02 ± 0.09 | 7.00 ± 0.00 | 5.46 ± 0.47 | 0.20 ± 0.01 | 70.49 ± 0.05 | 3.35 ± 0.25 |
| 64 | Alpinia purpurata | 28.97 ± 4.45 | 23.75 ± 2.06 | 62.85 ± 14.6 | 3.00 ± 0.00 | 1.40 ± 0.52 | 0.15 ± 0.03 | 87.88 ± 2.76 | 4.02 ± 0.14 |
| 65 | Hedychium coronarium | 2.31 ± 0.66 | 10.92 ± 1.78 | 13.08 ± 5.38 | 6.60 ± 0.21 | 2.64 ± 0.31 | 0.47 ± 0.04 | 94.70 ± 0.11 | 1.09 ± 0.01 |
| 66 | Hedychium coccineum | 0.23 ± 0.03 | 4.29 ± 0.61 | 1.73 ± 0.32 | 7.00 ± 0.00 | 5.00 ± 0.00 | 1.06 ± 0.09 | 42.04 ± 4.81 | 6.12 ± 1.32 |
| 67 | Renealmia alpinia | 0.24 ± 0.04 | 2.52 ± 0.27 | 0.52 ± 0.05 | 5.60 ± 0.21 | 4.00 ± 0.27 | 0.24 ± 0.03 | 53.70 ± 1.70 | 1.20 ± 0.01 |
| N° | Scientific Name | Total Carotenoids (mg β-Carotene/g DW) | Total Phenolics (mg GAE/g DW) | Total Anthocyanins (mg C-3-gl/g DW) | Citric Acid (mg/100 g DW) | Malic Acid (mg/100 g DW) | Tartaric Acid (mg/100 g DW) | Antioxidant Activity (mmol TE/g) ABTS | Antioxidant Activity (mmol TE/g) DPPH |
|---|---|---|---|---|---|---|---|---|---|
| 1 | M. erythrochlamys | 1.53 ± 0.02 | 76.09 ± 1.01 | 0.28 ± 0.03 | 116.4 ± 12.3 | 341.6 ± 5.2 | 213.4 ± 8.0 | 6.04 ± 0.70 | 31.89 ± 2.79 |
| 2 | O. cuspidatum | 3.04 ± 0.00 | 223.24 ± 4.66 | 0.20 ± 0.04 | 320.9 ± 7.5 | 141.7 ± 3.1 | 59.2 ± 3.4 | 5.96 ± 1.04 | 20.76 ± 0.57 |
| 3 | P. lutea | 83.03 ± 8.81 | 104.41 ± 0.75 | 0.13 ± 0.02 | 142.6 ± 1.0 | 112.8 ± 3.8 | 54.8 ± 1.2 | 2.50 ± 0.40 | 23.42 ± 3.49 |
| 4 | S. oblonga | 2.95 ± 0.02 | 194.55 ± 6.28 | 0.16 ± 0.01 | 42.9 ± 3.5 | 322.8 ± 10.9 | 344.4 ± 5.9 | 4.63 ± 0.02 | 31.50 ± 2.89 |
| 5 | T. grandiflora | 0.82 ± 0.02 | 110.25 ± 0.54 | 0.16 ± 0.01 | 20.2 ± 1.8 | 74.0 ± 1.3 | 106.6 ± 6.6 | 5.22 ± 0.04 | 48.42 ± 3.75 |
| 6 | C. argentea | 1.33 ± 0.01 | 140.63 ± 0.85 | 0.10 ± 0.02 | 51.6 ± 3.3 | 122.3 ± 10.6 | 63.6 ± 1.2 | 2.47 ± 0.57 | 28.00 ± 0.67 |
| 7 | E. aquaticum | 15.04 ± 0.56 | 85.81 ± 2.03 | 0.36 ± 0.08 | 84.8 ± 1.5 | 4605.0 ± 308.3 | 103.0 ± 3.9 | 4.96 ± 0.07 | 32.26 ± 3.90 |
| 8 | A. cathartica | 32.53 ± 0.09 | 167.12 ± 3.72 | 0.16 ± 0.01 | 613.6 ± 19.9 | 261.3 ± 21.3 | 106.7 ± 0.0 | 3.70 ± 0.85 | 25.73 ± 2.07 |
| 9 | P. fragrantissimum | 1.80 ± 0.02 | 291.75 ± 10.84 | 0.59 ± 0.08 | 44.1 ± 0.9 | 249.1 ± 1.3 | 22.0 ± 0.3 | 6.09 ± 0.92 | 33.41 ± 1.14 |
| 10 | P. strictum | 1.81 ± 0.05 | 353.57 ± 17.01 | 0.72 ± 0.15 | 923.3 ± 64.9 | 241.3 ± 7.1 | 13.6 ± 0.3 | 4.84 ± 0.60 | 46.05 ± 2.11 |
| 11 | X. robustum | 0.59 ± 0.01 | 94.45 ± 3.11 | 0.50 ± 0.16 | 391.9 ± 3.5 | 37.8 ± 0.9 | 34.3 ± 1.0 | 5.05 ± 0.03 | 47.75 ± 1.88 |
| 12 | A. papposa | 211.00 ± 0.57 | 92.39 ± 1.21 | 0.31 ± 0.06 | 112.7 ± 6.6 | 262.6 ± 43.8 | 104.8 ± 0.3 | 3.96 ± 0.02 | 36.53 ± 4.46 |
| 13 | D. pinnata | 1.11 ± 0.03 | 199.65 ± 2.50 | 1.84 ± 0.19 | 106.8 ± 23.7 | 1735.6 ± 275.3 | 92.7 ± 15.2 | 4.46 ± 0.20 | 65.79 ± 7.14 |
| 14 | D. balsapampae | 129.43 ± 12.75 | 133.07 ± 2.89 | 2.04 ± 0.12 | 168.5 ± 18.9 | 156.9 ± 10.2 | 226.9 ± 2.5 | 5.86 ± 0.08 | 64.46 ± 9.82 |
| 15 | P. chenopodioides | 1.87 ± 0.01 | 114.09 ± 4.62 | 0.31 ± 0.03 | 206.5 ± 2.8 | 431.4 ± 10.8 | 316.2 ± 5.8 | 4.55 ± 0.04 | 21.02 ± 0.87 |
| 16 | I. hancockii | 2.07 ± 0.11 | 165.15 ± 18.36 | 0.40 ± 0.01 | 39.1 ± 3.5 | 30.3 ± 0.0 | 35.7 ± 1.2 | 7.33 ± 0.10 | 32.73 ± 5.26 |
| 17 | I. hawkeri | 18.82 ± 0.65 | 215.17 ± 2.00 | 0.69 ± 0.09 | 105.9 ± 4.6 | 360.5 ± 20.3 | 222.9 ± 17.2 | 5.04 ± 0.03 | 77.77 ± 5.82 |
| 18 | I. sodenii | 23.86 ± 2.34 | 253.43 ± 11.18 | 0.30 ± 0.02 | 125.8 ± 9.2 | 95.5 ± 0.7 | 116.8 ± 2.3 | 4.07 ± 0.15 | 54.92 ± 6.94 |
| 19 | I. walleriana | 19.83 ± 1.83 | 288.17 ± 4.94 | 0.77 ± 0.03 | 76.7 ± 1.7 | 229.0 ± 2.6 | 129.5 ± 1.6 | 4.22 ± 1.00 | 73.23 ± 6.44 |
| 20 | A. corymbosa | 12.95 ± 0.14 | 302.67 ± 14.21 | 0.50 ± 0.05 | 62.4 ± 4.7 | 298.4 ± 1.8 | 31.3 ± 1.2 | 4.59 ± 0.04 | 67.63 ± 2.15 |
| 21 | G. nicaraguensis | 3.97 ± 0.06 | 87.75 ± 1.11 | 0.20 ± 0.02 | 254.3 ± 2.6 | 301.3 ± 28.6 | 48.7 ± 0.0 | 2.02 ± 0.08 | 32.61 ± 5.38 |
| 22 | R. veitchii | 1.35 ± 0.01 | 72.62 ± 0.49 | 0.04 ± 0.00 | 272.1 ± 3.1 | 979.4 ± 16.4 | 836.6 ± 16.4 | 4.00 ± 0.06 | 16.29 ± 1.00 |
| 23 | C. cornutus | 1.11 ± 0.01 | 262.11 ± 15.33 | 0.23 ± 0.04 | 956.7 ± 34.6 | 11655.9 ± 251.3 | 75.6 ± 1.6 | 2.86 ± 0.46 | 34.61 ± 2.44 |
| 24 | C. papaya | 2.43 ± 0.02 | 223.18 ± 7.29 | 0.23 ± 0.03 | 435.0 ± 10.6 | 490.9 ± 12.3 | 313.7 ± 13.2 | 5.02 ± 0.26 | 27.81 ± 2.79 |
| 25 | I. triloba | 0.62 ± 0.08 | 157.49 ± 14.03 | 0.37 ± 0.09 | 1333.2 ± 89.2 | 651.9 ± 2.1 | 30.5 ± 0.1 | 5.74 ± 0.05 | 23.96 ± 4.85 |
| 26 | C. spiralis | 0.69 ± 0.04 | 121.13 ± 0.44 | 0.76 ± 0.06 | 137.7 ± 10.7 | 109.8 ± 5.2 | 4.8 ± 0.3 | 5.26 ± 0.01 | 18.48 ± 1.44 |
| 27 | C. nitida | 1.18 ± 0.01 | 292.34 ± 8.24 | 0.91 ± 0.05 | 713.8 ± 76.6 | 225.5 ± 11.7 | 170.7 ± 23.4 | 3.88 ± 0.90 | 33.25 ± 3.28 |
| 28 | C. bracteata | 1.00 ± 0.09 | 232.83 ± 6.52 | 0.08 ± 0.00 | 443.7 ± 1.5 | 186.7 ± 3.4 | 143.4 ± 9.5 | 5.03 ± 0.02 | 25.84 ± 4.21 |
| 29 | C. cuatrecasasii | 0.25 ± 0.02 | 108.28 ± 6.40 | 0.16 ± 0.00 | 48.7 ± 7.8 | 1002.6 ± 5.8 | 188.6 ± 20.3 | 5.02 ± 0.03 | 40.99 ± 3.91 |
| 30 | C. nobilis | 0.73 ± 0.04 | 151.12 ± 4.14 | 0.03 ± 0.00 | 260.8 ± 18.6 | 278.3 ± 12.0 | 157.7 ± 29.7 | 5.01 ± 0.07 | 17.89 ± 2.61 |
| 31 | T. floribunda | 1.39 ± 0.03 | 259.37 ± 3.35 | 0.29 ± 0.06 | 3516.1 ± 154.1 | 209.4 ± 18.9 | 87.8 ± 10.2 | 7.80 ± 0.06 | 52.46 ± 3.96 |
| 32 | A. poiretii | 2.54 ± 0.06 | 269.57 ± 2.06 | 0.73 ± 0.06 | 205.4 ± 19.6 | 15613.6 ± 1238.4 | 55.2 ± 4.6 | 2.95 ± 0.47 | 44.11 ± 5.50 |
| 33 | B. macrophylla | 1.58 ± 0.05 | 299.60 ± 4.87 | 2.44 ± 0.38 | 114.3 ± 0.8 | 85.9 ± 1.3 | 51.8 ± 0.3 | 5.06 ± 0.02 | 56.74 ± 7.54 |
| 34 | C. angustifolia | 2.18 ± 0.05 | 337.21 ± 3.78 | 0.17 ± 0.01 | 158.8 ± 10.3 | 123.5 ± 12.8 | 196.0 ± 6.2 | 4.68 ± 0.03 | 49.59 ± 1.38 |
| 35 | E. americana | 0.84 ± 0.04 | 258.43 ± 14.93 | 0.35 ± 0.05 | 2874.9 ± 101.0 | 656.1 ± 13.8 | 439.3 ± 13.6 | 4.31 ± 1.00 | 39.36 ± 3.48 |
| 36 | M. sodiroana | 1.41 ± 0.16 | 175.38 ± 36.04 | 0.88 ± 0.13 | 142.3 ± 0.5 | 60.7 ± 1.2 | 6.9 ± 0.2 | 3.31 ± 0.48 | 16.74 ± 1.50 |
| 37 | G. ichthyoderma | 0.66 ± 0.06 | 251.00 ± 13.57 | 0.37 ± 0.04 | 28.0 ± 0.4 | 186.5 ± 1.9 | 334.7 ± 2.4 | 3.86 ± 0.89 | 47.84 ± 2.16 |
| 38 | H. episcopalis | 1.55 ± 0.13 | 56.86 ± 0.50 | 0.09 ± 0.00 | 346.9 ± 6.0 | 761.3 ± 12.6 | 17.4 ± 0.3 | 3.02 ± 0.03 | 29.28 ± 3.04 |
| 39 | H. collinsiana | 1.78 ± 0.01 | 300.94 ± 13.94 | 0.15 ± 0.04 | 92.1 ± 7.3 | 1553.1 ± 8.4 | 104.1 ± 0.8 | 4.57 ± 0.02 | 24.92 ± 3.65 |
| 40 | H. latispatha | 0.43 ± 0.01 | 86.40 ± 1.09 | 0.11 ± 0.06 | 45.0 ± 10.0 | 114.6 ± 0.5 | 5488.2 ± 70.6 | 4.65 ± 0.02 | 15.98 ± 0.70 |
| 41 | H. rostrata | 2.49 ± 0.08 | 155.21 ± 9.89 | 0.57 ± 0.01 | 164.9 ± 14.1 | 637.7 ± 4.1 | 357.0 ± 75.7 | 2.56 ± 0.26 | 22.53 ± 1.77 |
| 42 | H. wagneriana | 2.43 ± 0.00 | 288.17 ± 4.94 | 0.18 ± 0.04 | 3800.5 ± 104.4 | 1327.4 ± 40.0 | 61.0 ± 1.1 | 4.22 ± 1.00 | 46.45 ± 3.57 |
| 43 | P. vulgaris | 1.92 ± 0.05 | 110.69 ± 10.96 | 0.34 ± 0.06 | 90.5 ± 0.2 | 141.8 ± 14.7 | 25.0 ± 3.1 | 4.99 ± 0.04 | 59.43 ± 6.32 |
| 44 | H. rosa-sinensis | 3.64 ± 0.13 | 290.30 ± 9.67 | 1.93 ± 0.45 | 17818.6 ± 475.5 | 1693.8 ± 48.2 | 46.1 ± 7.2 | 7.67 ± 0.12 | 62.15 ± 1.08 |
| 45 | S. stromanthoides | 2.64 ± 0.00 | 50.60 ± 1.55 | 0.18 ± 0.03 | 39.6 ± 5.6 | 55.5 ± 6.8 | 5.6 ± 1.9 | 2.63 ± 0.08 | 24.73 ± 3.20 |
| 46 | P. heteromallum | 0.93 ± 0.05 | 344.22 ± 2.63 | 7.35 ± 0.43 | 88.5 ± 7.9 | 2254.1 ± 33.6 | 51.3 ± 0.9 | 4.18 ± 0.95 | 56.30 ± 2.91 |
| 47 | A. lepidotus | 1.42 ± 0.04 | 246.19 ± 16.01 | 0.29 ± 0.05 | 56.1 ± 0.7 | 5591.2 ± 64.0 | 137.4 ± 9.8 | 7.43 ± 0.13 | 31.76 ± 4.02 |
| 48 | C. mollis | 0.86 ± 0.07 | 354.20 ± 1.20 | 1.67 ± 0.08 | 51.1 ± 3.3 | 161.5 ± 6.8 | 708.2 ± 32.6 | 5.01 ± 0.07 | 55.69 ± 5.02 |
| 49 | P. urvilleana | 1.00 ± 0.04 | 510.53 ± 34.59 | 1.01 ± 0.01 | 55.2 ± 13.4 | 3540.8 ± 173.8 | 255.7 ± 25.7 | 4.66 ± 0.03 | 53.66 ± 4.49 |
| 50 | M. velutina | 0.92 ± 0.04 | 219.08 ± 8.51 | 0.42 ± 0.01 | 105.3 ± 10.6 | 846.2 ± 62.5 | 39.6 ± 8.1 | 6.58 ± 0.08 | 26.27 ± 3.13 |
| 51 | B. spectabilis | 2.65 ± 0.02 | 327.01 ± 8.42 | 0.06 ± 0.00 | 175.2 ± 12.5 | 394.0 ± 4.4 | 3197.1 ± 401.1 | 5.65 ± 0.07 | 29.85 ± 2.64 |
| 52 | E. aurantiacus | 1.12 ± 0.08 | 74.77 ± 2.06 | 0.13 ± 0.02 | 59.6 ± 7.2 | 293.1 ± 2.8 | 154.2 ± 11.4 | 4.98 ± 0.04 | 28.42 ± 3.65 |
| 53 | Oncidium sp. | 13.76 ± 0.12 | 99.11 ± 4.48 | 0.75 ± 0.06 | 201.0 ± 9.2 | 216.0 ± 1.8 | 171.3 ± 12.0 | 5.01 ± 0.08 | 26.56 ± 1.05 |
| 54 | S. liliastrum | 0.62 ± 0.01 | 97.89 ± 3.01 | 0.14 ± 0.03 | 365.5 ± 8.0 | 735.3 ± 56.3 | 30.6 ± 0.1 | 3.37 ± 0.11 | 38.61 ± 5.56 |
| 55 | M. erythrophylla | 0.92 ± 0.11 | 153.47 ± 3.39 | 0.74 ± 0.06 | 171.8 ± 5.7 | 740.0 ± 16.4 | 350.4 ± 14.9 | 5.11 ± 0.03 | 55.21 ± 9.54 |
| 56 | M. philippica | 1.99 ± 0.05 | 202.06 ± 7.07 | 0.17 ± 0.03 | 24.9 ± 1.6 | 87.3 ± 7.6 | 7.5 ± 0.58 | 5.03 ± 0.03 | 25.33 ± 5.74 |
| 57 | P. angustifolia | 0.84 ± 0.09 | 79.42 ± 1.43 | 0.21 ± 0.05 | 126.2 ± 9.6 | 3121.3 ± 260.7 | 92.5 ± 7.6 | 2.54 ± 0.04 | 18.64 ± 1.46 |
| 58 | B. arborea | 0.89 ± 0.04 | 153.37 ± 16.54 | 0.16 ± 0.05 | 878.1 ± 25.9 | 13.2 ± 0.5 | 197.1 ± 6.1 | 4.29 ± 0.03 | 27.70 ± 3.26 |
| 59 | I. gesnerioides | 1.15 ± 0.03 | 273.93 ± 5.84 | 0.47 ± 0.05 | 2662.8 ± 1581 | 666.3 ± 8.0 | 276.8 ± 9.7 | 5.74 ± 0.02 | 30.59 ± 6.11 |
| 60 | B. americana | 2.01 ± 0.02 | 165.91 ± 19.98 | 0.16 ± 0.01 | 782.6 ± 54.2 | 483.3 ± 22.8 | 1519.5 ± 33.5 | 4.40 ± 0.02 | 75.87 ± 4.75 |
| 61 | B. versicolor | 3.10 ± 0.16 | 120.74 ± 9.98 | 0.13 ± 0.04 | 1366.5 ± 67.7 | 764.5 ± 29.9 | 116.3 ± 0.1 | 4.70 ± 0.37 | 52.89 ± 4.57 |
| 62 | S. dulcamara | 3.65 ± 0.02 | 110.94 ± 7.18 | 0.40 ± 0.01 | 498.5 ± 34.6 | 182.1 ± 7.9 | 67.3 ± 0.2 | 4.96 ± 0.03 | 19.35 ± 4.53 |
| 63 | L. rugulosa | 0.89 ± 0.05 | 268.80 ± 13.73 | 0.31 ± 0.01 | 195.4 ± 15.4 | 1152.5 ± 13.5 | 34.0 ± 0.09 | 4.78 ± 1.13 | 40.97 ± 2.21 |
| 64 | A. purpurata | 1.33 ± 0.04 | 344.68 ± 5.80 | 1.32 ± 0.08 | 58.1 ± 0.4 | 189.5 ± 9.6 | 38.6 ± 1.0 | 5.72 ± 0.06 | 37.98 ± 3.63 |
| 65 | H. coronarium | 1.19 ± 0.00 | 75.57 ± 1.11 | 0.52 ± 0.07 | 214.9 ± 13.8 | 89.1 ± 2.9 | 16.0 ± 1.2 | 3.78 ± 0.05 | 30.00 ± 4.07 |
| 66 | H. coccineum | 1.71 ± 0.10 | 86.60 ± 0.81 | 0.23 ± 0.04 | 245.2 ± 1.51 | 100.7 ± 4.9 | 14.9 ± 0.6 | 4.90 ± 0.20 | 24.57 ± 1.36 |
| 67 | R. alpinia | 292.50 ± 0.89 | 34.50 ± 0.77 | 0.29 ± 0.00 | 142.1 ± 1.10 | 98.3 ± 3.2 | 9.2 ± 0.6 | 4.85 ± 0.20 | 42.11 ± 2.78 |
| N° | Scientific Name | Gallic Acid | Protocatechuic Acid | p-Coumaric Acid | m-Coumaric Acid | Syringic Acid | Chlorogenic Acid | 4-Hydroxibenzoic Acid | Caffeic Acid | Ferulic Acid | Rutin | Quercetin | Quercetin Glucoside | Kamferol | Total |
|---|---|---|---|---|---|---|---|---|---|---|---|---|---|---|---|
| 1 | M. erythrochlamys | 41.1 ± 1.3 | 778.8 ± 7.6 | 725.3 ± 53.8 | 2196.2 ± 39.8 | 135.0 ± 6.1 | 450.0 ± 3.1 | 118.4 ± 9.6 | 4444.8 ± 89.8 | ||||||
| 2 | O. cuspidatum | 24.0 ± 1.0 | 349.1 ± 8.4 | 2536.1 ± 11.7 | 1957.5 ± 34.9 | 712.1 ± 16.5 | 5578.8 ± 72.4 | ||||||||
| 3 | P. lutea | 92.3 ± 4.1 | 117.8 ± 1.3 | 46.8 ± 4.5 | 666.3 ± 41.2 | 225.5 ± 3.4 | 235.8 ± 4.4 | 1384.6 ± 39.6 | |||||||
| 4 | S. oblonga | 17.6 ± 1.2 | 159.4 ± 1.3 | 60.6 ± 1.5 | 17.6 ± 1.1 | 820.8 ± 60.5 | 2605.1 ± 48.5 | 33.6 ± 0.4 | 3714.7 ± 108.9 | ||||||
| 5 | T. grandiflora | 212.6 ± 2.1 | 302.2 ± 6.0 | 106.5 ± 0.2 | 509.9 ± 35.9 | 5848.8 ± 8.6 | 814.8 ± 4.5 | 7795.2 ± 36.1 | |||||||
| 6 | C. argentea | 81.8 ± 2.7 | 41.5 ± 1.2 | 164.7 ± 3.7 | 242 ± 30.1 | 67.2 ± 0.5 | 431.2 ± 11.7 | 89.6 ± 3.2 | 1118.0 ± 45.2 | ||||||
| 7 | E. aquaticum | 13.2 ± 0.6 | 43.3 ± 1.7 | 621 ± 4.9 | 227.5 ± 1.0 | 602.6 ± 22.9 | 1507.6 ± 31.1 | ||||||||
| 8 | A. cathartica | 21.1 ± 2.0 | 503.9 ± 6.1 | 219.9 ± 13.9 | 66.3 ± 5.0 | 133.6 ± 12.7 | 307.7 ± 31.5 | 637 ± 32.9 | 140.4 ± 23.2 | 138.9 ± 13.5 | 2168.6 ± 128.7 | ||||
| 9* | P. fragrantissimum | 15.5 ± 0.6 | 22.5 ± 3.4 | 148.7 ± 11.8 | 655.0 ± 7.1 | ||||||||||
| 10 | P. strictum | 78.4 ± 4.1 | 427.3 ± 0.4 | 793.8 ± 1.1 | 1299.5 ± 4.8 | ||||||||||
| 11 | X. robustum | 46.2 ± 1.3 | 36.3 ± 0.2 | 224.7 ± 0.8 | 141.6 ± 22.2 | 380.6 ± 12.9 | 152.1 ± 4.2 | 981.6 ± 30.1 | |||||||
| 12* | A. papposa | 24.3 ± 0.1 | 164.2 ± 1.3 | 165.0 ± 6.5 | 128.1 ± 2.7 | 1514.7 ± 56.8 | 204.8 ± 22.3 | 2208.3 ± 86.9 | |||||||
| 13 | D. pinnata | 114.1 ± 0.1 | 122.7 ± 2.7 | 601.3 ± 23 | 5118.6 ± 23.8 | 1047.4 ± 161.9 | 8235.5 ± 214.8 | 15239.6 ± 8.9 | |||||||
| 14* | D. balsapampae | 314.3 ± 6.6 | 308.8 ± 4.8 | 657.5 ± 1.3 | 2712.3 ± 66 | ||||||||||
| 15 | P. chenopodioides | 37.2 ± 2.2 | 104.0 ± 2.2 | 118.7 ± 0.8 | 207.1 ± 4.8 | 159.1 ± 10.3 | 626.0 ± 6.3 | ||||||||
| 16* | I. hancockii | 14.5 ± 0.4 | 28.6 ± 0.5 | 23.5 ± 0.5 | 133.5 ± 6.8 | 108.6 ± 15.0 | 148.2 ± 7.5 | 152 ± 1.3 | 117.1 ± 0.9 | 117.8 ± 0.3 | 851.1 ± 26.7 | ||||
| 17 | I. hawkeri | 42.5 ± 1.3 | 42.7 ± 0.4 | 632.3 ± 0.8 | 104.4 ± 1.5 | 185.9 ± 7.8 | 2202.9 ± 32.7 | 100.0 ± 4.6 | 3310.7 ± 5.5 | ||||||
| 18 | I. sodenii | 32.7 ± 2.9 | 55 ± 4.2 | 378.5 ± 17.8 | 450.0 ± 3.1 | 2405 ± 115.7 | 577.5 ± 25.2 | 3448.7 ± 165.2 | |||||||
| 19 | I. walleriana | 53.6 ± 5.3 | 59.6 ± 0.6 | 613.0 ± 14.4 | 126.4 ± 2.2 | 183.9 ± 6.1 | 2838.4 ± 42.5 | 164.6 ± 2.0 | 4039.4 ± 17.2 | ||||||
| 20 | A. corymbosa | 52.3 ± 2.0 | 25.6 ± 0.3 | 138.3 ± 4.2 | 5892.5 ± 172.2 | 757 ± 2 | 123.7 ± 13.1 | 6989.3 ± 159.1 | |||||||
| 21 | G. nicaraguensis | 30.5 ± 1.1 | 186.1 ± 4.6 | 736.5 ± 46.9 | 1443.6 ± 7.0 | 557.8 ± 56.2 | 2954.5 ± 113.6 | ||||||||
| 22* | R. veitchii | 89.6 ± 1.5 | 100.9 ± 8.5 | 477.2 ± 0.7 | 333.2 ± 8.8 | 258.2 ± 0.3 | 176.0 ± 10.5 | 1460.9 ± 12.7 | |||||||
| 23 | C. cornutus | 869.4 ± 2.0 | 1267.6 ± 96.0 | 329 ± 4.4 | 168.4 ± 0.3 | 2013.0 ± 2.8 | 4647.4 ± 99.3 | ||||||||
| 24 | C. papaya | 80.6 ± 3.1 | 4005 ± 113.3 | 810.2 ± 1.5 | 4895.8 ± 108.7 | ||||||||||
| 25 | I. triloba | 117.3 ± 3.4 | 304.6 ± 3.0 | 947.5 ± 99.3 | 32.8 ± 3.0 | 1402.2 ± 102.7 | |||||||||
| 26* | C. spiralis | 32.9 ± 1.1 | 314.3 ± 1.8 | 147.1 ± 13.2 | 59.8 ± 3.2 | 583.4 ± 16.3 | |||||||||
| 27* | C. nitida | 27.4 ± 0.0 | 38.7 ± 2.1 | 356 ± 24.3 | 55.3 ± 0.0 | 59.1 ± 3.4 | 1449.2 ± 60.7 | ||||||||
| 28 | C. bracteata | 2928.5 ± 97.2 | 240.2 ± 9.2 | 291.2 ± 10.6 | 3459.9 ± 117 | ||||||||||
| 29* | C. cuatrecasasii | 27.2 ± 1.1 | 1170.4 ± 34.0 | 77.5 ± 2.1 | 91.4 ± 4.5 | 192.3 ± 6.5 | 46.7 ± 6.0 | 1640.4 ± 12.3 | |||||||
| 30 | C. nobilis | 2149.5 ± 14.8 | 158.8 ± 2.1 | 204 ± 8.8 | 2512.2 ± 35.8 | ||||||||||
| 31* | T. floribunda | 10.4 ± 0.2 | 252.4 ± 18.5 | 1133 ± 63.5 | 552 ± 30.6 | 1960.3 ± 112.5 | |||||||||
| 32 | A. poiretii | 81.5 ± 0.7 | 12,044.3 ± 58.7 | 3224.7 ± 9.5 | 15,350.2 ± 35.6 | ||||||||||
| 33 | B. macrophylla | 4.3 ± 0.1 | 133.2 ± 1.0 | 345.8 ± 9.7 | 439.3 ± 4.4 | 65.7 ± 1.2 | 59.1 ± 1.1 | 106.1 ± 1.7 | 41.5 ± 1.4 | 1194.9 ± 18.7 | |||||
| 34 | C. angustifolia | 51.4 ± 3.4 | 1960.5 ± 1.2 | 709.4 ± 12.3 | 113.2 ± 0.9 | 3814.4 ± 10.1 | 175.6 ± 1.6 | 6824.5 ± 29.5 | |||||||
| 35 | E. americana | 92.4 ± 6.2 | 402.9 ± 41.9 | 4811.2 ± 24.3 | 150.1 ± 2.2 | 908.5 ± 21.3 | 306.0 ± 10.8 | 6671 ± 58.2 | |||||||
| 36 | M. sodiroana | 42.6 ± 0.1 | 196.7 ± 10.4 | 463.9 ± 18.8 | 5390.4 ± 28.8 | 73.5 ± 0.2 | 177.4 ± 3.0 | 101.5 ± 1.4 | 281.0 ± 13.3 | 6727.1 ± 328.6 | |||||
| 37* | G. ichthyoderma | 3.6 ± 0.1 | 3561.9 ± 79.8 | 6952.4 ± 153.6 | |||||||||||
| 38* | H. episcopalis | 65.6 ± 0.9 | 59.3 ± 1.9 | 11.5 ± 0.9 | 185.5 ± 8.1 | 16.9 ± 1.0 | 338.9 ± 7.2 | ||||||||
| 39 | H. collinsiana | 30.8 ± 1.4 | 52.6 ± 0.3 | 45.1 ± 1.7 | 73.0 ± 1.6 | 180.4 ± 0.6 | 431.0 ± 1.2 | ||||||||
| 40 | H. latispatha | 36.1 ± 0.2 | 89.2 ± 7.2 | 125.8 ± 8.3 | 234.1 ± 2.6 | 18.5 ± 0.1 | 28.1 ± 0.6 | 531.8 ± 12.6 | |||||||
| 41 | H. rostrata | 44.7 ± 4.6 | 102.5 ± 6.4 | 387.5 ± 3.3 | 272.0 ± 17.3 | 403.6 ± 24.6 | 469.0 ± 6.2 | 1679.3 ± 49.6 | |||||||
| 42 | H. wagneriana | 359 ± 15.7 | 30.2 ± 1.3 | 432.3 ± 6.5 | 33.8 ± 1.6 | 140.6 ± 4.4 | 69.7 ± 1.6 | 1065.5 ± 6.0 | |||||||
| 43 | P. vulgaris | 18.3 ± 0.6 | 77.9 ± 1.2 | 771.8 ± 36.2 | 3784.4 ± 268.3 | 57.3 ± 0.6 | 80.9 ± 2.4 | 4790.5 ± 308.2 | |||||||
| 44* | H. rosa-sinensis | 20.6 ± 0.3 | 7022.9 ± 330.0 | 263.8 ± 1.8 | 81.8 ± 1.0 | 8428.7 ± 334.9 | |||||||||
| 45 | S. stromanthoides | 20.4 ± 1.4 | 11.0 ± 0.5 | 45.3 ± 2.4 | 214.9 ± 3.1 | 130.2 ± 7.2 | 636.7 ± 12.9 | 54.0 ± 0.1 | 66.6 ± 2.3 | 68.5 ± 1.7 | 1247.4 ± 9.9 | ||||
| 46 | P. heteromallum | 54 ± 0.4 | 1850.7 ± 56.8 | 68.5 ± 2.3 | 1973.2 ± 54.1 | ||||||||||
| 47 | A. lepidotus | 32 ± 1.1 | 24.3 ± 0.8 | 313.4 ± 7.2 | 2799.6 ± 67.3 | 3169.3 ± 60.4 | |||||||||
| 48* | C. mollis | 172.8 ± 9.3 | 822 ± 13.4 | 724.4 ± 2.2 | 472.1 ± 5.7 | 2907.3 ± 19.2 | |||||||||
| 49 | P. urvilleana | 97.9 ± 1.9 | 175.1 ± 7.5 | 480.8 ± 2.9 | 207.9 ± 10.3 | 229.2 ± 19.9 | 1190.8 ± 6.9 | ||||||||
| 50 | M. velutina | 48.4 ± 0.3 | 20.0 ± 0.6 | 177.2 ± 11.0 | 90.5 ± 1.6 | 336.1 ± 12.9 | |||||||||
| 51 | B. spectabilis | 429.7 ± 14.9 | 755.9 ± 10.9 | 92.6 ± 1.9 | 435.2 ± 19.5 | 2850.1 ± 66 | 4563.5 ± 40.6 | ||||||||
| 52* | A. comata | 57.4 ± 0.4 | 653.7 ± 20.4 | 5824 ± 68.2 | |||||||||||
| 53 | Oncidium sp. | 47.31 ± 1.2 | 262.2 ± 3.1 | 207.2 ± 17.8 | 110.7 ± 2.4 | 1071.4 ± 6.6 | 236.5 ± 6.3 | 1935.3 ± 37.4 | |||||||
| 54 | S. liliastrum | 68.5 ± 2.3 | 191.1 ± 0.2 | 345.9 ± 12.7 | 280.3 ± 3.8 | 163.1 ± 12.6 | 102.9 ± 4.1 | 354.3 ± 9.0 | 1506.1 ± 6.3 | ||||||
| 55 | M. erythrophylla | 5.0 ± 0.2 | 16.1 ± 0.3 | 226.7 ± 29.2 | 37.1 ± 3.3 | 702.4 ± 54.6 | 2959.5 ± 144.2 | 4814.2 ± 137.3 | 176.9 ± 17.3 | 383.1 ± 86.5 | 587.8 ± 68.5 | 110,363.7 ± 431.8 | |||
| 56 | M. philippica | 547.6 ± 28.2 | 1349.8 ± 32.6 | 940.8 ± 26.3 | 3552.1 ± 23.8 | 6390.3 ± 110.8 | |||||||||
| 57 | P. angustifolia | 11.5 ± 1.6 | 231.4 ± 11.9 | 425.7 ± 7.3 | 173.3 ± 1.3 | 430.3 ± 3.0 | 1272.3 ± 19 | ||||||||
| 58 | B. arborea | 316.3 ± 1.9 | 10,729.0 ± 167.0 | 91.1 ± 2.0 | 78.3 ± 2.8 | 11,214.7 ± 173.7 | |||||||||
| 59 | I. gesnerioides | 245.8 ± 5.7 | 2738.4 ± 190.6 | 83.1 ± 2.7 | 55.1 ± 2.4 | 3122.4 ± 191.2 | |||||||||
| 60 | B. americana | 95.5 ± 3.5 | 1279.4 ± 114.5 | 596.3 ± 0.0 | 825.9 ± 24.6 | 2797.1 ± 142.6 | |||||||||
| 61 | B. versicolor | 106.2 ± 0.9 | 1231.2 ± 57.3 | 809.2 ± 30.9 | 2556.1 ± 293.8 | 775.9 ± 45.2 | 545.6 ± 42 | 203.3 ± 11.9 | 6227.5 ± 758.4 | ||||||
| 62 | S. dulcamara | 898.7 ± 2.4 | 3435 ± 65.4 | 4333.7 ± 67.8 | |||||||||||
| 63* | L. rugulosa | 32.4 ± 0.8 | 2326.9 ± 1.6 | 2949.5 ± 27.9 | 998.0 ± 14.7 | 6368.6 ± 9.6 | |||||||||
| 64* | A. purpurata | 15.5 ± 0.6 | 558.3 ± 43.2 | 1410.9 ± 65.0 | 498.9 ± 19.0 | 235.6 ± 13.3 | 282.8 ± 11.8 | 3147.4 ± 172.4 | |||||||
| 65 | H. coronarium | 24.0 ± 0.6 | 4.6 ± 0.5 | 43.9 ± 0.8 | 112.9 ± 1.7 | 232.0 ± 2.9 | 56.9 ± 0.8 | 602.0 ± 1.4 | 88.6 ± 2.8 | 1164.8 ± 2.0 | |||||
| 66 | H. coccineum | 13.3 ± 0.4 | 17.5 ± 0.4 | 43.1 ± 1.2 | 146.5 ± 17.0 | 41.8 ± 3.1 | 39.4 ± 0.7 | ||||||||
| 67 | R. alpinia | 6.3 ± 0.1 | 6.3 ± 0.2 |
| N° | Flower Extracts | Extract Concentration (mg/mL) | Zone of Inhibition (mm) | |||||
|---|---|---|---|---|---|---|---|---|
| Bacterial strain | Fungal strain | |||||||
| E. coli ATCC 8739 | S. aureus ATCC 6538P | P. aeruginosa ATCC 9027 | S. mutans ATCC 25175 | C. albicans ATCC 1031 | C. tropicalis ATCC 13803 | |||
| 1 | M. erythrochlamys | 162.4 | - | 12.5 ± 2.1 | - | - | - | - |
| 2 | O. cuspidatum | 127.5 | - | - | - | - | - | - |
| 4 | S. oblonga | 157.8 | - | 11.5 ± 0.7 | - | - | - | |
| 5 | T. grandiflora | 130.2 | - | - | - | 10.0 ± 0.0 | - | - |
| 6 | C. argentea | 104.4 | - | 11.5 ± 0.7 | - | - | - | - |
| 8 | A. cathartica | 66.7 | - | 7.5 ± 0.7 | - | - | - | - |
| 9 | P. fragrantissimum | 97.0 | - | 14.0 ± 0.0 | 10.5 ± 0.7 | 10.5 ± 0.7 | - | - |
| 10 | P. strictum | 127.9 | 10.5 ± 0.7 | 12.5 ± 0.7 | - | 10.0 ± 2.8 | - | - |
| 11 | X. robustum | 127.2 | - | 10.5 ± 0.7 | 10.0 ± 0.0 | - | - | - |
| 13 | D. pinnata | 132.7 | - | 8.5 ± 2.1 | - | - | - | |
| 20 | A. corymbosa | 75.0 | - | 11.5 ± 0.7 | - | - | - | - |
| 21 | G. nicaraguensis | 128.6 | - | - | - | - | - | - |
| 22 | R. veitchii | 81.0 | - | 7.5 ± 0.7 | - | - | - | - |
| 26 | C. spiralis | 334.9 | 13.0 ± 0.0 | 11.0 ± 1.4 | 11.0 ± 0.0 | - | - | - |
| 30 | C. nobilis | 251.2 | 15.5 ± 0.7 | 20.5 ± 0.7 | 13.0 ± 2.8 | 16.0 ± 0.0 | - | - |
| 32 | Acalypha poiretii | 300.0 | 10.5 ± 0.7 | 17.0 ± 1.4 | 12.0 ± 4.2 | 13.0 ± 0.0 | - | - |
| 33 | B. macrophylla | 550.5 | 10.5 ± 0.7 | 16.0 ± 1.4 | 10.5 ± 0.7 | 17.0 ± 0.0 | - | - |
| 35 | E. americana | 223.1 | 10.5 ± 0.7 | 10.0 ± 0.0 | - | 15.5 ± 0.7 | - | - |
| 37 | G. ichthyoderma | 174.8 | - | 14.5 ± 0.7 | - | - | - | - |
| 38 | H. episcopalis | 255.6 | - | 11.5 ± 0.7 | - | - | - | - |
| 41 | H. rostrata | 281.2 | - | 13.5 ± 2.1 | - | 10.0 ± 0.0 | - | - |
| 42 | H. wagneriana | 71.9 | - | 7.0 ± 0.0 | - | - | - | - |
| 47 | S. stromanthoides | 336.9 | - | 10.0 ± 1.4 | - | - | - | - |
| 46 | P. heteromallum | 255.6 | 10.5 ± 0.7 | 18.5 ± 0.8 | 15.0 ± 1.4 | 21.0 ± 0.0 | 13.0 ± 0.0 | - |
| 50 | M. velutina | 159.2 | - | 12.0 ± 1.4 | - | 12.0 ± 0.0 | - | - |
| 51 | B. spectabilis | 143.3 | - | 13.0 ± 0.0 | - | 22.0 ± 0.0 | - | - |
| 52 | E. aurantiacus | 131.2 | - | 11.5 ± 0.7 | - | - | - | |
| 53 | Oncidium sp | 110.1 | - | - | - | - | ||
| 55 | M. erythrophylla | 127.2 | 15.0 ± 0.0 | 14.5 ± 0.7 | - | - | ||
| 56 | M. philippica | 302.9 | - | 12.0 ± 1.4 | - | - | - | - |
| 57 | P. angustifolia | 125.6 | - | 8.5 ± 0.7 | - | - | - | - |
| 61 | B. versicolor | 132.5 | 9.0 ± 1.4 | 12.0 ± 0.0 | - | - | - | - |
| 62 | S. dulcamara | 111.3 | - | - | - | - | - | - |
| 65 | H. coronarium | 127.8 | 8.5 ± 0.7 | 15.0 ± 1.4 | - | - | - | - |
| 66 | H. coccineum | 146.2 | - | 8.0 ± 1.4 | - | - | - | - |
| Control * | 21.0 ± 2.1 | 24.8 ± 1.8 | 24.0 ± 1.2 | 30.0 ± 3.9 | 12.9 ± 1.4 | 18.9 ± 3.0 | ||
Disclaimer/Publisher’s Note: The statements, opinions and data contained in all publications are solely those of the individual author(s) and contributor(s) and not of MDPI and/or the editor(s). MDPI and/or the editor(s) disclaim responsibility for any injury to people or property resulting from any ideas, methods, instructions or products referred to in the content. |
© 2024 by the authors. Licensee MDPI, Basel, Switzerland. This article is an open access article distributed under the terms and conditions of the Creative Commons Attribution (CC BY) license (https://creativecommons.org/licenses/by/4.0/).
Share and Cite
Coyago-Cruz, E.; Barrigas, A.; Guachamin, A.; Heredia-Moya, J.; Zuñiga-Miranda, J.; Vera, E. Bioactive Composition of Tropical Flowers and Their Antioxidant and Antimicrobial Properties. Foods 2024, 13, 3766. https://doi.org/10.3390/foods13233766
Coyago-Cruz E, Barrigas A, Guachamin A, Heredia-Moya J, Zuñiga-Miranda J, Vera E. Bioactive Composition of Tropical Flowers and Their Antioxidant and Antimicrobial Properties. Foods. 2024; 13(23):3766. https://doi.org/10.3390/foods13233766
Chicago/Turabian StyleCoyago-Cruz, Elena, Alejandro Barrigas, Aida Guachamin, Jorge Heredia-Moya, Johana Zuñiga-Miranda, and Edwin Vera. 2024. "Bioactive Composition of Tropical Flowers and Their Antioxidant and Antimicrobial Properties" Foods 13, no. 23: 3766. https://doi.org/10.3390/foods13233766
APA StyleCoyago-Cruz, E., Barrigas, A., Guachamin, A., Heredia-Moya, J., Zuñiga-Miranda, J., & Vera, E. (2024). Bioactive Composition of Tropical Flowers and Their Antioxidant and Antimicrobial Properties. Foods, 13(23), 3766. https://doi.org/10.3390/foods13233766

